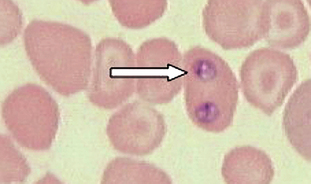
image

This chapter discusses the roles that veterinary technicians play in assisting the veterinarian in diagnosing endoparasites (internal parasites) of domestic animals such as dogs, cats, cattle, horses, sheep, and poultry. Diagnosis of endoparasitism is one of the most frequently performed procedures in the veterinary clinical setting. As such, diagnoses must be performed accurately and efficiently so that the appropriate treatment may be initiated.
An accurate diagnosis of endoparasitism is based primarily on the veterinarian’s and the technician’s awareness of parasites that are prevalent in the immediate geographic area or ecosystem. However, because of the far-ranging mobility of owners and their pets in the twenty-first century, residence in or travel to another geographic region also should be considered when endoparasitism is among several differential diagnoses.
Heavily parasitized animals often show clinical signs suggestive of the infected organ system. Depending on the affected organ system, these signs may include diarrhea or constipation, anorexia, vomiting, blood in the stool, or fat in the stool. Parasitized animals are frequently lethargic and display an unthrifty appearance characterized by weight loss or stunted growth, dull haircoat, dehydration, or anemia. The animal also may experience coughing or labored breathing.
Internal parasites of domestic animals comprise several types of organisms that live internally in animals, feed on their tissues or body fluids, or compete directly for their food. These organisms range in size from being too small to be seen with the naked eye (microscopic) to being more than 1 m in length. Parasites also vary in their location within the host and in the means by which they are transmitted from one host to another. Because of these diverse variations, no single diagnostic test can identify all endoparasites.
The veterinary technician may be asked to perform a wide variety of diagnostic procedures to diagnose endoparasitism. These procedures usually detect the adult stages of a parasite or their eggs or larval stages in the animal’s feces, urine, or blood. In addition, a variety of immunologic tests are available for confirming the presence of both metazoan and protozoan parasites infecting domestic animals. Mature parasites are seldom found because they are generally hidden within the body of the animal. The only way to detect their presence is by using an immunologic test or performing a necropsy, or postmortem dissection. An assorted battery of diagnostic procedures may not be in common use in veterinary practices but are described in this chapter because they may be useful to veterinary technicians working in research or diagnostic laboratories.
This chapter includes illustrations and brief descriptions of some of the eggs, larvae, and adult parasites that may be diagnosed in common domesticated animals. Sometimes eggs of certain groups of parasites are quite similar; differentiation of individual species or genera based on their morphologic characteristics may be difficult or impossible. Parasites with similar eggs usually are differentiated by fecal culture and larval identification.
The technician must remember that the diagnostic tests used to detect endoparasitism may be unreliable. An animal may be infected with endoparasites; however, if the infection is slight, no eggs or larvae may be observed in the specimens tested. If an inappropriate test is used, it is also possible that no parasites may be detected. Another common problem is trying to diagnose endoparasitism before the parasite completely develops. Many parasites can produce clinical disease before they become reproductively mature.
The time elapsed between initial infection with a parasite until the infection can be detected by using common diagnostic procedures is called the prepatent period. The best example of this concept is trying to diagnose hookworm disease (Ancylostoma caninum) in a 1-week-old puppy by observation of eggs on fecal flotation. This attempted diagnosis is a waste of time because the minimum time for infection until adult hookworms are present in the bowel and begin to produce eggs (prepatent period) is 12 days. The astute veterinary practitioner uses fecal flotation results but also the puppy’s history, clinical signs, and other laboratory tests (e.g., blood values) to arrive at a specific diagnosis of ancylostomiasis (infection with hookworms).
Complete coverage of the discipline of veterinary parasitology is beyond the scope of this text. Only the general types of parasites of domestic animals and their life cycle stages that may be recovered by commonly used diagnostic procedures are described. The reference texts listed at the end of this chapter provide more detailed coverage of veterinary parasitology and specific parasites.
Internal parasites, called endoparasites, live within an animal. These parasites derive their nutrition and protection at the expense of the infected animal, which is called the host. The various internal parasites have many different life cycles. Each parasite’s life cycle is distinctive and is composed of various developmental stages, all of which may occur within the same host or separately within sequential hosts.
The host that harbors the adult, mature, or sexual stages of a parasite is called the definitive host. The dog is the definitive host for Dirofilaria immitis; adult male and female heartworms are found in the right ventricle and pulmonary arteries of the dog’s heart. The host that harbors the larval, immature, or asexual stages of a parasite is called the intermediate host. The mosquito is the intermediate host for D. immitis; first, second, and third larval stages of D. immitis are found within the mosquito intermediate host.
The life cycle of most parasites has at least one stage at which the parasite may be passed from one host to the next. Diagnostic procedures frequently detect this stage; therefore it is referred to as the diagnostic stage. The diagnostic stage of a parasite may leave the host through excreta, such as feces or urine, or it may be transmitted from the bloodstream to its next host by an arthropod, such as a mosquito. The microfilarial stage is the diagnostic stage of D. immitis; the female mosquito takes in the microfilariae during a blood meal.
Protozoa are unicellular, or one-cell, organisms, some of which may be parasitic in domestic animals. These protozoans can infect a variety of tissue sites within the definitive host. The most common sites for their detection are in blood samples, in which they are called blood protozoa or hemoprotozoa, or within fecal samples, in which they are called intestinal protozoa. The protozoan’s life cycle may be either simple or complex.
Most hemoprotozoa seen in the United States are found in erythrocytes (red blood cells [RBCs]) within a stained blood smear. Ticks usually serve as intermediate hosts and transmit the RBCs containing the hemoprotozoa from one animal to the next. Babesia bigemina is a tear-shaped or pear-shaped hemoprotozoan found within the RBCs of infected cattle. It is transmitted by Boophilus annulatus, a tick described in Chapter 7.
Trypanosomes are another group of hemoprotozoans occasionally found in the United States. Rather than being found within RBCs, trypanosomes are extracellular and “swim” within the blood. They are 3 to 10 times as long as an RBC is wide and are banana shaped. They have a lateral undulating membrane and a thin, whiplike tail (flagellum) that is used for swimming. These parasites are also transmitted by blood-feeding arthropods (see reduviid bugs in Chapter 7).
The trematodes (also called flukes) are flatworms with unsegmented, leaf-shaped bodies. In domestic animals in the United States, most adult flukes are found in the intestinal tract, the liver, or even the lungs. In these sites, the hermaphroditic (having male and female sex organs) flukes lay eggs that are passed in the feces. The end portion of many fluke eggs has a small cap, lid, or door; this structure is called an operculum and is common among many of the flukes.
Within each fluke egg is a larval stage known as a miracidium, which hatches and exits the egg through the operculum. This stage penetrates the first intermediate host, which is usually a snail. Within the snail, the miracidium develops into a sporocyst, which then produces many tiny internal structures called rediae. Each redia may produce many internal cercariae. The cercaria exits the snail and may take one of three pathways to enter the definitive host: it may develop into a metacercaria and encyst upon vegetation, whereby it is ingested by the definitive host; it may be ingested by a second intermediate host and become encysted as the metacercarial stage within that host, which is subsequently ingested by the definitive host; or the cercaria may directly penetrate the skin of the definitive host.
Flukes of veterinary importance include the liver flukes of cattle and sheep (Fasciola hepatica, Fascioloides magna, Dicrocoelium dendriticum) and the lung fluke of dogs and cats (Paragonimus kellicotti).
Like trematodes, cestodes (tapeworms) are also flatworms. They are also hermaphroditic. They differ, however, in that cestodes are ribbonlike and divided into a long chain of proglottids, which are segments connected like train cars behind a scolex or “head,” by which the tapeworm attaches to the wall of the host’s intestine. Most tapeworms release their proglottids one at a time or in short chains into the feces. Proglottids in the feces can be observed with the naked eye. A few tapeworms release eggs directly from the worm’s uterus.
Tapeworm proglottids have muscles that enable them to move about. Pet owners often observe these tapeworms as “little white worms” crawling on the pet’s feces, haircoat, or bedding. These fresh proglottids are said to resemble “cucumber seeds.” When the proglottids dry out, they resemble uncooked grains of rice.
Tapeworm proglottids often contain eggs when they are passed into the feces. These eggs contain hexacanth embryos, which are embryos with an internal structure with six hooks.
An intermediate host, usually a mammalian host, such as a rabbit, ingests these hexacanth embryos. The hexacanth embryo grows within the tissues of the intermediate host to a “bladderworm” stage, which is a fluid-filled larval stage. The definitive host becomes infected by ingesting the intermediate host, which contains the bladderworm larval stage. Examples of tapeworms that develop into the bladderworm stage in the intermediate host are the canine taeniid tapeworm (Taenia pisiformis) and the coenurus tapeworm (Multiceps multiceps). In some tapeworms (Echinococcus granulosus, Echinococcus multilocularis), the larval stage within the vertebrate host is a hydatid cyst.
When the intermediate host is an arthropod, such as a flea or a grain mite, the hexacanth embryo develops into a microscopic larval stage known as a cysticercoid. The cysticercoid stage is tiny and contains a small fluid-filled space. The definitive host becomes infected by ingesting the intermediate host, which contains the cysticercoid larval stage. The cysticercoid stage is associated with the fringed tapeworm of cattle (Thysanosoma actinoides) and the double-pore tapeworm (Dipylidium caninum) of dogs and cats.
Nematodes often are referred to as roundworms and are one of the most important groups of parasites in veterinary parasitology. They may be found in almost any tissue of domestic animals, including the intestines, skin, lungs, kidneys, urinary bladder, nervous tissue, musculature, and blood.
Nematodes as a group have diverse, complicated life cycles. They have separate sexes (male nematodes and female nematodes). Their eggs or larvae are most commonly recovered from the feces. The eggs of nematodes infecting the kidney or urinary bladder may be recovered from the urine.
Examples of intestinal nematodes found in dogs include large roundworms (Toxocara canis, Toxascaris leonina), hookworms (Ancylostoma caninum, Uncinaria stenocephala), and whipworms (Trichuris vulpis). Urinary roundworms include canine kidney worms (Dioctophyma renale). Respiratory roundworms include the lungworms of cattle and sheep (Dictyocaulus species and Muellerius capillaris). Nematodes of the blood vasculature are a special group, of which the heartworm of dogs (Dirofilaria immitis) is an example. Adult female heartworms give birth to small, wormlike prelarval (embryonic) stages called microfilariae. The microfilariae may be observed in a peripheral blood smear and are approximately 310 μm long. Within the mosquito, the microfilariae develop into infective third-stage larvae. These infective larvae are transmitted to other animals by the infected mosquitoes.
Acanthocephalans (thorny-head worms) are uncommon parasites with complicated life cycles. Like the nematodes, they have separate sexes. On the cranial end of these helminths is a spiny proboscis, which is used to attach to the lining of the intestine wall. Thorny-head worms do not have a true gut; they absorb nutrients through their body wall. Acanthocephalans usually are recovered at necropsy.
The most famous acanthocephalan is Macracanthorhynchus hirudinaceus, a parasite of pigs. This parasite has the dubious honor of possessing the longest scientific name among the parasites of domestic animals. Oncicola canis is an acanthocephalan found in the small intestine of dogs.
Following are descriptions of most of the common endoparasites in domestic animals in the United States. Information is given on the organ or organ system parasitized in the host; prepatent period, or time from initial infection until the diagnostic stage may be recovered, where appropriate; description of the diagnostic stage, or life cycle stage commonly used to make a diagnosis, such as eggs or larvae; and diagnostic stage most commonly identified.
Parasites of the Gastrointestinal Tract
Nematodes (Roundworms): Spirocerca lupi, the esophageal worm, is a nematode that often forms nodules (granulomas) in the esophageal wall of dogs and cats. Occasionally it may be found in nodules in the stomach of cats. Adult worms reside deep within these nodules and expel their eggs through fistulous openings in the granuloma. Eggs are passed into the lumen of the host animal’s esophagus and pass out in the feces. The thick-shelled eggs are 30 to 38 μm by 11 to 15 μm and contain a larva when they are laid. These eggs have a unique paper-clip shape. Figure 6-1 shows the characteristic ovum of S. lupi. Eggs usually may be observed on fecal flotation and may be recovered when vomitus has been subjected to a standard fecal flotation procedure. Radiographic or endoscopic examination may reveal characteristic granulomas within the esophagus or within the stomach. The prepatent period is 6 months.

Figure 6-1 Characteristic ovum of Spirocerca lupi. The thick-shelled eggs contain larvae and measure 30 to 38 μm by 11 to 15 μm. Eggs usually may be observed on fecal flotation and may be recovered when vomitus has been subjected to a standard fecal flotation procedure. (From Hendrix CM, Robinson E: Diagnostic parasitology for veterinary technicians, ed 3, St Louis, 2006, Mosby.)
Physaloptera species are stomach worms of dogs and cats. Although they occasionally are found in the lumen of the stomach or small intestine, Physaloptera species usually are firmly attached to the mucosal surface of the stomach, where they suck blood. At this site, these nematodes may be viewed with an endoscope. Their diet consists of blood and tissue derived from the host’s gastric mucosa. Their attachment sites continue to bleed after the parasite detaches. Vomiting, anorexia, and dark, tarry stools may be observed in affected animals.
The adults are creamy white, sometimes tightly coiled, and 1.3 to 4.8 cm long. They are often recovered in the pet’s vomitus and may be confused with ascarids, or roundworms. A quick way to differentiate these two parasites is to break open an adult specimen and (if that specimen happens to be female) examine the released eggs microscopically. The eggs of Physaloptera species are small, smooth, thick shelled, and embryonated when passed in the feces. Eggs are 30 to 34 μm by 49 to 58 μm and contain a larva when they are laid. Figure 6-2 shows the characteristic ovum of Physaloptera species. Eggs usually may be recovered on a standard fecal flotation by using solutions with a specific gravity greater than 1.25. The prepatent period is 56 to 83 days.

Figure 6-2 Characteristic ovum of Physaloptera species. The oval, thick-shelled eggs contain larvae and measure 49 to 58 μm by 30 to 34 μm. Eggs usually may be recovered on a standard fecal flotation by using solutions with a specific gravity greater than 1.25. (From Hendrix CM, Robinson E: Diagnostic parasitology for veterinary technicians, ed 3, St Louis, 2006, Mosby.)
Aonchotheca putorii is commonly referred to as the gastric capillarid of cats. It was once known by a former name, Capillaria putorii. This capillarid frequently parasitizes mustellids, such as mink, but it also has been reported in cats. These nematodes are rarely reported in North America. The eggs of A. putorii are easily confused with other trichinelloid nematodes (see the section on feline whipworms). Their eggs are 53 to 70 μm by 20 to 30 μm and exhibit a netlike surface similar to that of the eggs of Eucoleus aerophilus, an upper respiratory capillarid. The eggs of A. putorii are dense, less delicate than those of E. aerophilus, and organized in a longitudinal formation. They have flattened sides and contain a one- or two-cell embryo, which fills the egg.
Ollulanus tricuspis is “the feline trichostrongyle.” This parasite usually is associated with vomiting in cats. It is most commonly identified by examination of the cat’s vomitus with a dissecting or compound microscope. Feline vomitus also may be examined by a standard fecal flotation procedure. The best flotation solution for identification is a modified Sheather’s flotation solution. Adult female O. tricuspis are 0.8 to 1.0 mm long and have three major tail cusps, which are the origin of the name tricuspis. Adult males are 0.7 to 0.8 mm long and have a copulatory bursa. The female worms are viviparous (bear live young). The infective third-stage larvae (500 by 22 μm) mature to adults in the cat’s stomach. Free-living stages are not required for completion of the life cycle. Transmission occurs through ingestion of vomitus from infected cats.
Toxocara canis, Toxocara cati, and Toxascaris leonina are the ascarids of dogs and cats. These roundworms are found in the small intestine of dogs and cats in most areas of the world. All young puppies and kittens presented to a veterinary clinic should be examined for these large, robust nematodes. Adult ascarids may vary from 3 to 18 cm in length and when passed are usually tightly coiled, much like a coiled bedspring. The eggs of Toxocara species are spherical, with a deeply pigmented center and a rough, pitted outer shell (Fig. 6-3). Eggs of T. canis are 75 to 90 μm in diameter, whereas those of T. cati are smaller, only 65 to 75 μm in diameter (Fig. 6-4). The eggs of Toxascaris leonina are spherical to ovoid, with dimensions of 75 μm by 85 μm. These eggs have a smooth outer shell and a hyaline or “ground glass” central portion. Figure 6-5 shows the characteristic ovum of T. leonina. The prepatent period for T. canis is 21 to 35 days, whereas that of T. leonina is 74 days.

Figure 6-3 Characteristic ovum of Toxocara species. These eggs are spherical, with a deeply pigmented center and a rough, pitted outer shell. Eggs of T. canis are 75 to 90 μm in diameter. (From Hendrix CM, Robinson E: Diagnostic parasitology for veterinary technicians, ed 3, St Louis, 2006, Mosby.)

Figure 6-4 Characteristic ovum of Toxocara cati. These eggs are smaller than those of T. canis, measuring only 65 to 75 μm in diameter. (From Hendrix CM, Robinson E: Diagnostic parasitology for veterinary technicians, ed 3, St Louis, 2006, Mosby.)

Figure 6-5 Characteristic ovum of Toxascaris leonina. These eggs are spherical to ovoid, with dimensions of 75 by 85 μm. They have a smooth outer shell and a hyaline or “ground glass” central portion. (From Hendrix CM, Robinson E: Diagnostic parasitology for veterinary technicians, ed 3, St Louis, 2006, Mosby.)
Ancylostoma caninum, a canine hookworm; Ancylostoma tubaeforme, a feline hookworm; Ancylostoma braziliense, a canine and feline hookworm; and Uncinaria stenocephala, a northern canine hookworm, are small intestinal nematodes. Hookworms are found throughout the world and are common in tropical and subtropical areas of North America. Hookworm infection, which can produce severe anemia in young kittens and puppies, can be a serious problem in kennels and catteries. The prepatent period depends on the species of hookworm and the route of infection.
Eggs of all hookworm species are oval or ellipsoid, have thin walls, and contain 8 to 16 cells when passed in the pet’s feces. Because these eggs larvate rapidly in the external environment (as early as 48 hours after feces are passed), fresh feces are needed for diagnosing hookworm infections. Eggs of A. caninum are 56 to 75 μm by 34 to 47 μm (Fig. 6-6). Those of A. tubaeforme are 55 to 75 μm by 34.4 to 44.7 μm. Those of A. braziliense are 75 μm by 45 μm and those of U. stenocephala are 65 to 80 μm by 40 to 50 μm. These eggs usually may be recovered on a standard fecal flotation.

Figure 6-6 Characteristic hookworm ovum. The eggs of Ancylostoma caninum are 56 to 75 μm by 34 to 47 μm, those of A. tubaeforme are 55 to 75 μm by 34.4 to 44.7 μm, those of A. braziliense are 75 μm by 45 μm, and those of U. stenocephala are 65 to 80 μm by 40 to 50 μm. (Reprinted from Hendrix CM, Robinson E: Diagnostic parasitology for veterinary technicians, ed 3, St Louis, 2006, Mosby.)
Strongyloides stercoralis and Strongyloides tumefaciens are often referred to as “intestinal threadworms.” These nematodes are unique; only a parthenogenetic female (female that can lay eggs without copulation with a male) is parasitic in the host. Parasitic males do not exist. These females produce eggs, but in dogs these eggs hatch in the intestine, releasing first-stage larvae. Figure 6-7 shows the parasitic adult females, eggs, and first-stage larvae of Strongyloides species. The larvae are 280 to 310 μm long and have a rhabditiform (club-shaped) esophagus, with a club-shaped cranial corpus, a narrow median isthmus, and a caudal bulb. The prepatent period is 8 to 14 days.

Figure 6-7 Parasitic adult females, eggs, and first-stage larvae of Strongyloides species. These larvae are 280 to 310 μm long and have a rhabditiform esophagus, with a club-shaped cranial corpus, a narrow median isthmus, and a caudal bulb. (Reprinted from Hendrix CM, Robinson E: Diagnostic parasitology for veterinary technicians, ed 3, St Louis, 2006, Mosby.)
Trichuris vulpis, the canine whipworm, and Trichuris campanula and Trichuris serrata, the feline whipworms, reside in the cecum and colon of their respective hosts. Canine whipworms are common, but feline whipworms are rare in North America and diagnosed only sporadically throughout the world. Whipworms derive their name from the fact that the adults have a thin, filamentous cranial end (i.e., the lash of the whip) and a thick caudal end (i.e., the handle of the whip). The egg of the whipworm is described as trichinelloid or trichuroid. It has a thick, yellow-brown, symmetric shell with polar plugs at both ends. The eggs are unembryonated (not larvated) when laid. Eggs of T. vulpis are 70 to 89 μm by 37 to 40 μm. Figure 6-8 shows the characteristic egg of T. vulpis. The prepatent period for T. vulpis is 70 to 90 days.

Figure 6-8 Characteristic ovum of Trichuris vulpis. Eggs of T. vulpis are 70 to 89 μm by 37 to 40 μm. (From Hendrix CM, Robinson E: Diagnostic parasitology for veterinary technicians, ed 3, St Louis, 2006, Mosby.)
The eggs of T. campanula and T. serrata may be easily confused with those of Aonchotheca putorii, Eucoleus aerophilus, and Personema feliscati, parasites of the feline stomach, respiratory tract, and urinary system, respectively. The eggs of T. campanula average 63 to 85 μm by 34 to 39 μm. When examining a cat’s feces for feline trichurids, the veterinary technician should be aware of pseudoparasites; the eggs of trichurids or capillarids frequently parasitize an outdoor cat’s prey: hosts such as mice, rabbits, or birds. The eggs of these trichurids or capillarids may pass unaltered through the cat’s gastrointestinal system, remaining intact and unembryonated and thus appearing to infect the feline host.
Enterobius vermicularis is the human pinworm and does not parasitize dogs or cats. Nevertheless, the family pet is often falsely incriminated by family practitioners or pediatricians as a source of pinworm infection in young children. The veterinary technician should remember this rule: Pinworms are parasites of omnivores (mice, rats, monkeys, human beings) and herbivores (rabbits, horses) but never carnivores (dogs, cats).
Cestodes (Tapeworms): Dipylidium caninum is often called the “double-pore” or “cucumber seed” tapeworm. This tapeworm is the most common tapeworm found in the small intestine of the dog and cat because the dog or cat becomes infected by ingesting the flea intermediate host. Fleas often contain this parasite’s infective cysticercoid stage. This tapeworm has motile, terminal, gravid proglottids, which usually are found on the feces (Fig. 6-9, A), on the pet’s haircoat, or in the bedding of the host. In the fresh state, these proglottids resemble cucumber seeds. These terminal proglottids have a lateral pore located along the midpoint of each of their long edges, the origin of the tapeworm’s other common name, the “double-pore” tapeworm (Fig. 6-9, B).

Figure 6-9 A, Characteristic motile, terminal, gravid proglottids of Dipylidium caninum on canine feces. In the fresh state, these proglottids resemble cucumber seeds; hence the common name, the “cucumber seed” tapeworm. B, These proglottids of D. caninum have a lateral pore along the midpoint of each long edge, thus the second common name, double-pored tapeworm. (From Hendrix CM, Robinson E: Diagnostic parasitology for veterinary technicians, ed 3, St Louis, 2006, Mosby.)
If fresh proglottids of D. caninum (Fig. 6-10, A) are teased or broken open, they may reveal thousands of unique egg packets, each containing 20 to 30 hexacanth embryos. Figure 6-10, B, shows the unique egg packet of D. caninum. The proglottids of D. caninum often dry out in the external environment. As they lose moisture, they shrivel up and resemble uncooked grains of rice (Fig. 6-10, C). If reconstituted with water, the dried proglottids usually assume their former cucumber seed appearance. The prepatent period for D. caninum is 14 to 21 days.

Figure 6-10 A, Gravid proglottids of Dipylidium caninum are filled with thousands of egg packets. B, Characteristic egg packet of D. caninum. Each egg packet may contain up to 30 hexacanth embryos. C, Dried proglottids of D. caninum resemble uncooked grains of rice. When water is added, they assume their natural state. (From Hendrix CM, Robinson E: Diagnostic parasitology for veterinary technicians, ed 3, St Louis, 2006, Mosby.)
Taenia pisiformis, Taenia hydatigena, and Taenia ovis are the canine taeniids. As with D. caninum, Taenia tapeworms appear as motile, terminal, gravid proglottids on the feces, on the pet’s haircoat, or in the bedding of the host. In the fresh state, these proglottids have a single lateral pore located along the midpoint of either of their long edges (as opposed to the double-pore tapeworm).
As with D. caninum, if these fresh proglottids are teased or broken open, they may reveal thousands of hexacanth embryos. The proglottids of Taenia species also dry out in the external environment and resemble uncooked grains of rice. If reconstituted with water, they too usually assume their former single-pore appearance. If gravid proglottids of Taenia species are recovered from a dog’s or cat’s feces, the proglottid should be torn open or macerated in a drop of saline solution on a glass slide to reveal the characteristic eggs under the compound microscope.
The eggs of taeniid tapeworms are slightly oval and are 43 to 53 μm by 43 to 49 μm in diameter (T. pisiformis), 36 to 39 μm by 31 to 35 μm in diameter (T. hydatigena), and 19 to 31 μm by 24 to 26 μm (T. ovis). Eggs of Taenia species contain a single oncosphere with three pairs of hooks. The oncosphere is the hexacanth embryo. Figure 6-11 shows the unique features of this taeniid tapeworm. The eggs are also similar to those of Echinococcus and Multiceps species.

Figure 6-11 Characteristic ova of the taeniid tapeworms are slightly oval and 43 to 53 μm by 43 to 49 μm in diameter (Taenia pisiformis), 36 to 39 μm by 31 to 35 μm in diameter (Taenia hydatigena), and 19 to 31 μm by 24 to 26 μm (Taenia ovis). Eggs of Taenia species contain a single oncosphere with three pairs of hooks. The oncosphere is often called a hexacanth embryo. The eggs are similar to those of Echinococcus and Multiceps species. The dissimilar ovum is that of A. caninum, the hookworm. (From Hendrix CM, Robinson E: Diagnostic parasitology for veterinary technicians, ed 3, St Louis, 2006, Mosby.)
Taenia taeniaeformis, or Hydatigera taeniaeformis, is called the “feline tapeworm” or the “feline taeniid.” This tapeworm is observed infrequently in cats allowed to roam and prey on house and field mice and rats. The egg of this tapeworm is 31 to 36 μm in diameter and contains a single oncosphere with three pairs of hooks. The oncosphere is often called a hexacanth embryo. As with the eggs of the canine taeniids, the eggs are similar to those of Echinococcus species (see Fig. 6-11).
Multiceps multiceps and Multiceps serialis also are tapeworms of the small intestine of canids. The eggs of M. multiceps are 29 to 37 μm in diameter, whereas those of M. serialis are elliptic and measure 31 to 34 μm by 29 to 30 μm. Both contain a single oncosphere with three pairs of hooks. As with the eggs of the canine and feline taeniids, the eggs of Multiceps species are similar to those of Echinococcus species (see Fig. 6-11).
Echinococcus granulosus and Echinococcus multilocularis are tapeworms associated with unilocular and multilocular hydatid disease. E. granulosus is the hydatid cyst tapeworm of dogs, whereas E. multilocularis is the hydatid cyst tapeworm of cats. These are important parasites because of their extreme zoonotic potential. The egg of E. granulosus is ovoid and 32 to 36 μm by 25 to 30 μm. It contains a single oncosphere with three pairs of hooks. The egg of E. multilocularis is ovoid and 30 to 40 μm. It contains a single oncosphere with three pairs of hooks. These eggs are very similar in appearance to those of Taenia and Multiceps species (see Fig. 6-11).
The adult Echinococcus is a tiny tapeworm, only 1.2 to 7.0 mm in length. The entire tapeworm has only three proglottids: one immature proglottid, one mature proglottid, and one gravid proglottid. When passed, the tiny gravid proglottids are so small that they are often overlooked by the client, the veterinary technician, and the veterinarian. Definitive diagnosis of Echinococcus infection is best achieved by identifying adult tapeworms taken from the host’s intestinal tract. In the rare instances in which Echinococcus infection is suspected, antemortem diagnosis is accomplished by purging the dog or cat with arecoline hydrobromide per os at 3.5 mg/kg and collecting the feces. This procedure usually is performed only when this infection is strongly suspected. Entire worms or their proglottids may be collected from the final clear mucus. Because of the severe zoonotic potential, all evacuated material should be handled with caution. Rubber gloves should be worn. After the feces have been examined, they should be incinerated.
Spirometra species are often referred to as “zipper” tapeworms or sparganosis tapeworms (Fig. 6-12). These tapeworms are often found in the small intestine of both the dog and cat and in pets in Florida and along the Gulf Coast of North America. This tapeworm is a clinical oddity because it produces an operculated egg. Each proglottid of Spirometra species has a central spiral uterus and an associated uterine pore through which eggs are released. These tapeworms characteristically release eggs until they exhaust their uterine contents. Gravid segments usually are not discharged into the pet’s feces.

Figure 6-12 Spent proglottids of Spirometra mansonoides, the “zipper tapeworm.” This tapeworm is unique because although it is attached to the host’s jejunum, the mature proglottids often separate along the longitudinal axis for a short distance. The tapeworm appears to “unzip,” which provides the origin for its common name. Spent “zipped” and “unzipped” proglottids often appear in the feces of the patient. (From Hendrix CM, Robinson E: Diagnostic parasitology for veterinary technicians, ed 3, St Louis, 2006, Mosby.)
The tapeworm is unique because while it is attached to the host’s jejunum, the mature proglottids often separate along the longitudinal axis for a short distance. The tapeworm appears to “unzip,” which is the origin of its common name, the “zipper tapeworm.” Spent “zipped” and “unzipped” proglottids often appear in the feces of the pet.
The egg of Spirometra species resembles that of a fluke, or digenetic trematode (Fig. 6-13). The egg has a distinct operculum at one end of the pole of the shell. The eggs are oval and yellowish-brown. They average 60 μm by 36 μm, have an asymmetric appearance, and are rather pointed at one end. When the eggs rupture, a distinct operculum is visible. The eggs are unembryonated when passed in the feces.

Figure 6-13 Characteristic ovum of Spirometra mansonoides. The egg of Spirometra species resembles that of a fluke (digenetic trematode). The egg has a distinct operculum at one end of the shell. The eggs are oval and yellowish-brown. They average 60 by 36 μm and have an asymmetric appearance. They tend to be rather pointed at one end. (From Hendrix CM, Robinson E: Diagnostic parasitology for veterinary technicians, ed 3, St Louis, 2006, Mosby.)
Diphyllobothrium species are often referred to as “broad fish” tapeworms. This tapeworm may be 2 to 12 m long; however, it probably does not grow as large as 12 m in dogs and cats. Each proglottid of this tapeworm has a central rosette-shaped uterus and an associated uterine pore through which eggs are released. These tapeworms continually release eggs until they exhaust their uterine contents. The terminal proglottids become senile rather than gravid and detach in chains rather than individually.
The egg of Diphyllobothrium species also resembles that of a fluke (digenetic trematode). The egg is oval and has a distinct operculum at one end of the shell. The eggs are light brown, averaging 67 to 71 μm by 40 to 51 μm. They tend to be rounded on one end. The operculum is present on the end opposite the rounded end. The eggs are unembryonated when passed in the feces.
Trematodes (Flukes): Platynosomum fastosum is the “lizard poisoning fluke” of cats (Fig. 6-14). The adult flukes inhabit the liver, gallbladder, bile ducts, and less commonly, the small intestine. The brownish, operculated eggs are 34 to 50 μm by 20 to 35 μm.

Figure 6-14 A, Characteristic ova of Platynosomum fastosum, the “lizard poisoning fluke” of cats. B, The brownish, operculated eggs are 34 to 50 μm by 20 to 35 μm. (From Hendrix CM, Robinson E: Diagnostic Parasitology for Veterinary Technicians, ed 3, St Louis, 2006, Mosby.)
Nanophyetus salmincola is the “salmon poisoning fluke” of dogs in the Pacific Northwest region of North America. The adult fluke inhabits the small intestine and serves as a vector for rickettsial agents, which produce “salmon poisoning” and “Elokomin fluke fever” in dogs. The eggs are unembryonated when laid and measure 52 to 82 μm by 32 to 56 μm (Fig. 6-15). They have an indistinct operculum and a small, blunt point at the end opposite the operculum.

Figure 6-15 Characteristic ovum of Nanophyetus salmincola. The eggs are unembryonated when laid and measure 52 to 82 μm by 32 to 56 μm. They have an indistinct operculum and a small, blunt point at the end opposite the operculum. (From Hendrix CM, Robinson E: Diagnostic parasitology for veterinary technicians, ed 3, St Louis, 2006, Mosby.)
Alaria species are intestinal flukes of dogs and cats and are found throughout the northern half of North America. Their ova are large, golden brown, and operculated (Fig. 6-16). They are 98 to 134 μm by 62 to 68 μm.

Figure 6-16 Characteristic ovum of Alaria species, the intestinal flukes of dogs and cats. They are found throughout the northern half of North America. The eggs are large, golden brown, and operculated. They measure 98 to 134 μm by 62 to 68 μm. (From Hendrix CM, Robinson E: Diagnostic parasitology for veterinary technicians, ed 3, St Louis, 2006, Mosby.)
Protozoans (Unicellular Organisms): Isospora species (coccidians) are protozoan parasites of the small intestine of both dogs and cats. They produce a clinical syndrome known as coccidiosis, one of the most commonly diagnosed protozoan diseases in puppies and kittens. Coccidiosis is rarely a problem in mature animals. The oocyst is the diagnostic stage observed in a fecal flotation of fresh feces. It is unsporulated in fresh feces and varies in size and shape among the common Isospora species (Figs. 6-17 and 6-18).

Figure 6-17 Unsporulated oocyst of Isospora species (left). Oocysts vary greatly in size. Also see Fig. 6-18, Ancylostoma caninum (right).

Figure 6-18 Sporulated oocyst of Isospora species. The canine coccidians and their measurements are Isospora canis, 34 to 40 μm by 28 to 32 μm; Isospora ohioensis, 20 to 27 μm by 15 to 24 μm; and Isospora wallacei, 10 to 14 μm by 7.5 to 9.0 μm. The feline coccidians and their measurements are Isospora felis, 38 to 51 μm by 27 to 29 μm, and Isospora rivolta, 21 to 28 μm by 18 to 23 μm. Ancylostoma caninum (right).
The canine coccidians and their oocyst measurements are Isospora canis, 34 to 40 μm by 28 to 32 μm; Isospora ohioensis, 20 to 27 μm by 15 to 24 μm; and Isospora wallacei, 10 to 14 μm by 7.5 to 9.0 μm. The feline coccidians and their measurements are Isospora felis, 38 to 51 μm by 27 to 29 μm, and Isospora rivolta, 21 to 28 μm by 18 to 23 μm. The prepatent period varies among species but is usually 7 to 14 days.
Toxoplasma gondii is another intestinal coccidian of cats. Its oocysts usually are diagnosed using a standard fecal flotation. Oocysts of T. gondii are unsporulated in fresh feces and measure 10 μm by 12 μm. Several immunodiagnostic tests using whole blood or serum are available for diagnosis of T. gondii infection. The prepatent period is highly variable, ranging from 5 to 24 days, and depends on the route of infection.
Cryptosporidium is another coccidian parasite that parasitizes the small intestine of a wide variety of animals, including dogs and cats, but particularly young calves. The sporulated oocysts in the feces are oval to spherical and measure only 4 to 6 μm. Diagnosis is by a standard fecal flotation. The oocysts are extremely small and may be observed just under the cover slip, not in the same plane of focus as other oocysts and parasite ova (Fig. 6-19). Examination of fresh fecal smears with special stains (modified acid-fast stain) is also helpful. Because people may become infected with Cryptosporidium species, feces suspected of harboring this protozoan should be handled with great care.

Figure 6-19 Oocysts of Cryptosporidium species. (From Hendrix CM, Robinson E: Diagnostic parasitology for veterinary technicians, ed 3, St Louis, 2006, Mosby.)
Sarcocystis is another coccidian parasite found in the small intestine. Several species infect dogs and cats. Identification of an individual species may be quite difficult. The oocysts of Sarcocystis species are sporulated when passed in the feces. Each oocyst contains two sporocysts, each with four sporozoites. These individual oocysts measure 12 to 15 μm by 8 to 12 μm and may be recovered in a standard fecal flotation of fresh feces.
Giardia species are flagellated protozoans often recovered from the feces of dogs and cats with diarrhea, but they also may be recovered from animals with normal stools. This parasite occurs in two morphologic forms: a motile feeding stage the trophozoite, (Fig. 6-20) and a resistant cyst stage. The motile stage is pear shaped and dorsoventrally flattened and contains four pairs of flagella. It measures 9 to 21 μm by 5 to 15 μm. Two nuclei and a prominent adhesive disk are present on the cranial portion of the cell, resembling a pair of eyes staring back at the observer.

Figure 6-20 Motile trophozoite of Giardia species. (From Hendrix CM, Robinson E: Diagnostic parasitology for veterinary technicians, ed 3, St Louis, 2006, Mosby.)
The mature cysts are oval and are 8 to 10 μm by 7 to 10 μm. They have a refractile wall and four nuclei. Immature cysts, which represent recently encysted motile forms, contain only two nuclei (Fig. 6-21). In dogs, diarrhea may begin as early as 5 days after exposure to Giardia, with cysts first appearing in the feces at 1 week.

Figure 6-21 Cysts of Giardia species. The mature cysts are oval and measure 8 to 10 μm by 7 to 10 μm. They have a refractile wall and four nuclei. Immature cysts, which represent recently encysted motile forms, contain only two nuclei. (From Hendrix CM, Robinson E: Diagnostic parasitology for veterinary technicians, ed 3, St Louis, 2006, Mosby.)
Diagnosis is by a standard fecal flotation. Zinc sulfate (specific gravity 1.18) is considered the best flotation medium for recovering cysts. Cysts are often distorted, with a semilunar appearance. The motile trophozoite occasionally may be found on a direct smear of fresh feces with isotonic saline. Lugol’s iodine may be used to visualize the internal structures of cysts and trophozoites. Fecal immunodiagnostic tests are also commonly used.
Nematodes (Roundworms): Dirofilaria immitis is often referred to as the canine heartworm; however, this nematode also has been known to parasitize cats and ferrets. Adult heartworms are found within the right ventricle, the pulmonary artery, and the fine branches of that artery. This parasite is often recovered in a variety of aberrant sites, such as the brain, the anterior chamber of the eye, and subcutaneous sites. The prepatent period in dogs is approximately 6 months.
In microfilaremic dogs, diagnosis is by observing microfilariae in blood samples using one of several concentration techniques (modified Knott’s test) or the commercially available filter techniques (Figs. 6-22 and 6-23). For infected dogs and cats with no circulating microfilariae, infection also may be diagnosed by commercially available immunodiagnostic tests.

Figure 6-22 Microfilariae of Dirofilaria immitis from a peripheral blood sample subjected to the modified Knott’s test. The microfilariae of D. immitis average 310 μm long. In contrast, the microfilariae of Dipetalonema reconditum average 285 μm long. (From Hendrix CM, Robinson E: Diagnostic parasitology for veterinary technicians, ed 3, St Louis, 2006, Mosby.)

Figure 6-23 An individual microfilaria of Dirofilaria immitis from a peripheral blood sample subjected to the modified Knott’s test. Note the tapered cranial end and straight tail. Microfilariae of Dipetalonema reconditum have a blunt (rounded) cranial end and may exhibit a shepherd’s crook (hooked) tail. (From Hendrix CM, Robinson E: Diagnostic parasitology for veterinary technicians, ed 3, St Louis, 2006, Mosby.)
A subcutaneous filariid of dogs, Dipetalonema reconditum, also produces microfilariae in the peripheral blood. The microfilariae of this nonpathogenic nematode must be differentiated from those of D. immitis (see Figs. 6-22 and 6-23).
Trematodes (Flukes): Heterobilharzia americanum, the canine schistosome, is a blood fluke that parasitizes the mesenteric veins of the small and large intestines and portal veins of the dog. This fluke is enzootic in the Mississippi delta and the coastal swampland of Louisiana. Although this fluke inhabits the vasculature, its presence is manifested by bloody diarrhea. Infected dogs also exhibit emaciation and anorexia. Diagnosis is by identification of the thin-shelled egg, approximately 80 μm by 50 μm, which contains a miracidium. Figure 6-24 shows the morphologic features of the egg of H. americanum. The prepatent period is approximately 84 days.
Protozoans (Unicellular Organisms): Babesia canis is an intracellular parasite found within the erythrocytes of dogs, also referred to as a piroplasm (pear-shaped body) (Fig. 6-25). Diagnosis is by observing basophilic, pear-shaped trophozoites in RBCs on stained blood smears.
Figure 6-25 Basophilic, pear-shaped trophozoites of Babesia canis within canine RBCs in a stained blood smear. (From Hendrix CM, Robinson E: Diagnostic parasitology for veterinary technicians, ed 3, St Louis, 2006, Mosby.)
Cytauxzoon felis is another intracellular parasite sporadically reported in the RBCs of cats in various locales (Missouri, Arkansas, Georgia, Texas) throughout the United States. It also produces piroplasms, which have been described as shaped like a “bejeweled ring” and are referred to as the ring form in stained blood smears. Cytauxzoonosis is a rapidly fatal disease, and its prognosis is poor.
Hepatozoon canis and Hepatozoon americanum are intracellular, malaria-like parasites affecting dogs. The blood forms of the parasites (the gamonts) of these protozoan parasites are found in the leukocytes. Leukocytes containing gamonts of H. canis are common in peripheral blood smears, whereas those of H. americanum are rare. Schizonts are found in endothelial cells of the spleen, bone marrow, and liver. The gamonts are surrounded by a delicate capsule and stain pale blue with a dark, reddish-purple nucleus. Numerous pink granules are found in the cytoplasm of the leukocyte. The “onion skin” tissue cysts of H. americanum are found in the skeletal muscle of dogs. (For cystic stages of this parasite, see Parasites of the Musculoskeletal System.) This is an unusual parasite in that the dog becomes infected by ingestion of an infected tick, Amblyomma americanum. H. canis is well adapted to its canine host and varies from producing a subclinical to a mild disease. H. americanum produces a violent and frequently fatal course of disease; it is theorized to have crossed the species barrier from a wild animal host to the domestic dog.
Pentastomids (Tongueworms): Pentastomids (tongueworms) resemble helminths but are actually related to the arthropods. Linguatula serrata is the “canine pentastome” or the “canine tongueworm” (Fig. 6-26). Pentastomes are usually parasites of snakes and reptiles, but this tongueworm parasitizes the nasal and respiratory passages of dogs. It resembles a helminth but is classified as a type of arthropod because it has a mitelike larval stage. The pentastome eggs measure 70 μm by 90 μm (Fig. 6-27). On the inside of the egg, the mitelike larval stage with its jointed claws is often visible.

Figure 6-26 Adult female Linguatula serrata, the “canine pentastome” or “canine tongueworm.” This parasite of the nasal and respiratory passages of dogs resembles a helminth, but it is actually a type of arthropod (it has a mitelike larval stage). (From Hendrix CM, Robinson E: Diagnostic parasitology for veterinary technicians, ed 3, St Louis, 2006, Mosby.)

Figure 6-27 Characteristic ovum of Linguatula serrata. The pentastome eggs measure 70 by 90 μm. In the interior of many pentastome eggs, a mitelike larval stage with jointed claws can be observed. (From Hendrix CM, Robinson E: Diagnostic parasitology for veterinary technicians, ed 3, St Louis, 2006, Mosby.)
Nematodes (Roundworms): Aelurostrongylus abstrusus is the feline lungworm. The adults live in the terminal respiratory bronchioles and alveolar ducts, where they form small egg nests or nodules. The eggs of this parasite are forced into the lung tissue, where they hatch to form characteristic first-stage larvae, approximately 360 μm long. Each larva has a tail with an S-shaped bend and a dorsal spine (Fig. 6-28). Characteristic larvae on fecal flotation or the Baermann technique can determine their presence. Recovering the larvae on tracheal washing is also possible (Fig. 6-29). The prepatent period is approximately 30 days.

Figure 6-28 Characteristic first-stage larva of Aelurostrongylus abstrusus, the feline lungworm. The larva is approximately 360 μm long and has a tail with an S-shaped bend and a dorsal spine. Diagnosis is accomplished by finding these characteristic larvae on fecal flotation or by using the Baermann technique. (From Hendrix CM, Robinson E: Diagnostic parasitology for veterinary technicians, ed 3, St Louis, 2006, Mosby.)

Figure 6-29 Numerous first-stage larvae of Aelurostrongylus abstrusus recovered on tracheal washing. (From Hendrix CM, Robinson E: Diagnostic parasitology for veterinary technicians, ed 3, St Louis, 2006, Mosby.)
Filaroides (Oslerus) osleri, Filaroides hirthi, and Filaroides milksi, the canine “lungworms,” are found in the trachea, the lung parenchyma, and the bronchioles of canids, respectively. The larva is 232 to 266 μm long and has a short, S-shaped tail. Filaroides species are unique among the nematodes in that their first-stage larvae are immediately infective for the canine definitive host. No period of development is required outside the host. Diagnosis is by finding these characteristic larvae on fecal flotation or by using the Baermann technique. Figure 6-30 shows the unique infective larvae of F. osleri. Nodules of F. osleri are usually found at the bifurcation of the trachea, where they can be observed by endoscopic examination. The prepatent period for F. osleri is approximately 10 weeks.

Figure 6-30 Characteristic infective first-stage larva of Filaroides osleri, a canine lungworm. The larva is 232 to 266 μm long and has a short, S-shaped tail. (From Hendrix CM, Robinson E: Diagnostic parasitology for veterinary technicians, ed 3, St Louis, 2006, Mosby.)
Eucoleus aerophilus (Capillaria aerophila) is a capillarid nematode found in the trachea and bronchi of both dogs and cats. The prepatent period is approximately 40 days. In standard fecal flotations, eggs of Eucoleus species are often confused with those of Trichuris (whipworms). Eggs of E. aerophilus are smaller than whipworm eggs (59 to 80 μm by 30 to 40 μm), more broadly barrel shaped, and lighter in color. The egg also has a rough outer surface with a netted appearance.
Eucoleus böehmi is found in the nasal cavity and frontal sinuses of dogs. Its eggs are smaller and have a smoother outer surface than those of E. aerophilus. Its shell has a pitted appearance. This parasite can be detected by standard fecal flotation.
Trematodes (Flukes): Paragonimus kellicotti is the “lung fluke” of dogs. Hermaphroditic adult flukes occur in cystic spaces within the lung parenchyma of both dogs and cats. These cystic spaces connect to the terminal bronchioles. The eggs are found in sputum or feces. The egg is yellowish-brown with an operculum and measures 75 to 118 μm by 42 to 67 μm (Fig. 6-31). Fluke eggs usually are recovered by fecal sedimentation techniques; however, the eggs of P. kellicotti may be recovered by standard fecal flotation solutions. The eggs of P. kellicotti also may be recovered in the sputum collected by tracheal washing. The adult flukes within the cystic spaces of the lung parenchyma can also be observed in thoracic radiographs. This fluke’s prepatent period is 30 to 36 days.

Figure 6-31 Characteristic ovum of Paragonimus kellicotti, the lung fluke of dogs recovered by standard fecal flotation. The eggs may be found in either sputum or feces but often are recovered on fecal flotation. The yellowish-brown, operculated eggs measure 75 to 118 μm by 42 to 67 μm. Ancylostoma caninum egg (left). (From Hendrix CM, Robinson E: Diagnostic parasitology for veterinary technicians, ed 3, St Louis, 2006, Mosby.)
Nematodes (Roundworms): Dioctophyma renale is the “giant kidney worm” of dogs. This largest of parasitic nematodes frequently infects the right kidney of dogs and gradually ingests the renal parenchyma, leaving only the capsule of the kidney. Eggs may be recovered by centrifugation and examination of the urine sediment. They are characteristically barrel shaped, bipolar, and yellow brown. The egg’s shell has a pitted appearance. Eggs measure 71 to 84 μm by 46 to 52 μm. Figure 6-32 shows the characteristic ovum of D. renale. D. renale also may occur freely within the peritoneal cavity. When it is in this location, eggs are not passed to the external environment. The prepatent period is approximately 18 weeks.

Figure 6-32 Characteristic ovum of Dioctophyma renale recovered from urine sediment. These eggs are characteristically barrel shaped, bipolar, and yellow brown. The egg shell has a pitted appearance. Eggs measure 71 to 84 μm by 46 to 52 μm. (From Hendrix CM, Robinson E: Diagnostic parasitology for veterinary technicians, ed 3, St Louis, 2006, Mosby.)
Capillaria plica and Capillaria (Personema) feliscati are nematodes of the urinary bladder of dogs and cats, respectively. Their eggs may be found in urine or in feces contaminated with urine. Eggs are clear to yellow in color, measure 63 to 68 μm by 24 to 27 μm, and have flattened bipolar end plugs. Their outer surface is roughened. These eggs may be confused with those of the respiratory and gastric capillarids and with those of the whipworms.
Nematodes (Roundworms): Thelazia californiensis is the “eyeworm” of dogs and cats. Adult parasites can be recovered from the conjunctival sac and lachrymal duct. Examination of the lachrymal secretions may reveal eggs or first-stage larvae. As mentioned previously, D. immitis may be recovered from a variety of aberrant sites, such as the anterior chamber of the eye.
Protozoans (Unicellular Parasites): In the United States, canine hepatozoonosis is most commonly diagnosed by muscle biopsy rather than by examination of peripheral blood smears for infected leukocytes. Muscle lesions consist of large cysts, pyogranulomas, and myositis. The cysts produced are round to ovoid and range from 250 to 500 μm in diameter. The center of the cyst demonstrates a basophilic nucleus surrounded by small basophilic bodies. Surrounding the nucleus and the basophilic bodies are concentric layers of fine multilaminated membranes, giving an “onion skin” appearance. In most cases, no inflammatory response is associated with the cyst (Fig. 6-33).
Parasites of the Gastrointestinal Tract
Nematodes (Roundworms): The bovine trichostrongyles are composed of several genera of nematodes within the abomasum and small and large intestine of cattle and other ruminants. Genera that produce trichostrongyle-type eggs are Bunostomum, Cooperia, Chabertia, Haemonchus, Oesophagostomum, Ostertagia, and Trichostrongylus. These seven genera (and others) produce oval, thin-shelled eggs. They contain four or more cells and are 70 to 120 μm long. Some of these ova may be identified to their respective genera; however, identification is usually difficult because mixed infections of bovine trichostrongyles are quite common.
Upon identification of the characteristic eggs, the veterinary technician should record the finding as a trichostrongyle-type egg (Fig. 6-34). They should never be recorded as individual genus names. Identification of genus and species usually can be performed only by fecal culture and larval identification.

Figure 6-34 Characteristic trichostrongyle-type ova of the bovine trichostrongyles. These oval, thin-shelled eggs contain four or more cells. They measure 70 to 120 μm long. Some of these ova can be identified by their respective genus; however, identification is usually difficult because mixed infections are common. (From Hendrix CM, Robinson E: Diagnostic parasitology for veterinary technicians, ed 3, St Louis, 2006, Mosby.)
Nematodirus species and Marshallagia species are also bovine trichostrongyles; however, their eggs are much larger than those of the genera mentioned previously. Their eggs are the largest in the trichostrongyle family. Figure 6-35 shows the large eggs of Nematodirus species. In a standard fecal flotation, the eggs of Nematodirus species are large (150 to 230 μm by 80 to 100 μm) and have tapering ends and four to eight cells. The eggs of Marshallagia species also are large (160 to 200 μm by 75 to 100 μm), have parallel sides and rounded ends, and contain 16 to 32 cells.

Figure 6-35 Characteristic large ova of Nematodirus species. In standard fecal flotation, the eggs of Nematodirus species are larger than those of other bovine trichostrongyles (150 to 230 μm by 80 to 100 μm), have tapering ends, and have four to eight cells. (From Hendrix CM, Robinson E: Diagnostic parasitology for veterinary technicians, ed 3, St Louis, 2006, Mosby.)
Strongyloides papillosus is often referred to as the “intestinal threadworm.” These nematodes are unique in that only a parthenogenetic female (female that lays eggs without copulating with a male) is parasitic in the host. Parasitic males do not exist. These females produce larvated eggs measuring 40 to 60 μm by 20 to 25 μm. Eggs usually are recovered in flotation of fresh feces. The prepatent period is 5 to 7 days. (See Fig. 6-7 for the parasitic adult females, eggs, and first-stage larvae of Strongyloides species.)
Trichuris ovis is commonly called the whipworm, infecting the cecum and colon of ruminants. The previous section on nematode parasites of the gastrointestinal tract of dogs and cats contains details regarding the gross morphologic characteristics of adult whipworms. The egg of the whipworm is described as trichinelloid or trichuroid. It has a thick, yellow-brown, symmetric shell with plugs at both ends. The eggs are unembryonated (not larvated) when laid. Eggs of bovine whipworms measure 50 to 60 μm by 21 to 25 μm.
Cestodes (Tapeworms): Moniezia species are tapeworms found in the small intestine of cattle, sheep, and goats. These tapeworms produce eggs with a characteristic cuboidal or pyramidal shape; under the compound microscope these eggs appear square or triangular in silhouette. Two species are common, Moniezia benedini in cattle and Moniezia expansa in cattle, sheep, and goats. The eggs of both species can be easily differentiated by standard fecal flotation procedures. Figure 6-36 shows representative eggs of Moniezia species. The eggs of M. expansa appear triangular and measure 56 to 67 μm in diameter. The eggs of M. benedini appear square and are approximately 75 μm in diameter. The prepatent period for these tapeworms is approximately 40 days.

Figure 6-36 Characteristic ova of Moniezia species. The eggs of Moniezia expansa are triangular or pyramidal and 56 to 67 μm in diameter. The eggs of Moniezia benedini are square or cuboidal and approximately 75 μm in diameter. (From Hendrix CM, Robinson E: Diagnostic parasitology for veterinary technicians, ed 3, St Louis, 2006, Mosby.)
Thysanosoma actinoides is the “fringed tapeworm” found in the bile ducts, pancreatic ducts, and small intestine of ruminants. Eggs of this tapeworm occur in packets of 6 to 12 eggs, with individual eggs measuring 19 by 27 μm.
Trematodes (Flukes): “Rumen flukes” are composed of two genera, Paramphistomum and Cotylophoron. These adult flukes reside in the rumen and reticulum of cattle, sheep, goats, and many other ruminants. The eggs of Paramphistomum species measure 114 to 176 μm by 73 to 100 μm, whereas the eggs of Cotylophoron species measure 125 to 135 μm by 61 to 68 μm. The prepatent period of Paramphistomum species is 80 to 95 days.
Fasciola hepatica is the “liver fluke” of cattle, sheep, and other ruminants. The hermaphroditic adult flukes are found in the bile ducts of the liver. The eggs measure 140 μm by 100 μm and are yellowish-brown, oval, and operculated (Fig. 6-37). The prepatent period for F. hepatica is approximately 56 days.

Figure 6-37 Characteristic operculated ovum of Fasciola hepatica, the liver fluke of cattle, sheep, and other ruminants. The eggs measure 140 by 100 μm and are yellowish-brown and oval. (From Hendrix CM, Robinson E: Diagnostic parasitology for veterinary technicians, ed 3, St Louis, 2006, Mosby.)
Dicrocoelium dendriticum is the “lancet fluke” of sheep, goats, and oxen. These tiny flukes reside within the fine branches of the bile ducts. The brown eggs have an indistinct operculum and measure 36 to 45 μm by 20 to 30 μm. Eggs of this and the aforementioned trematodes may be recovered from feces by fecal sedimentation or a commercially available fluke egg recovery test.
Protozoans (Unicellular Organisms): Ruminants serve as host to many species of Eimeria. Identification of individual species of coccidia is often difficult because their oocysts are so similar in size and shape. The two most common species of coccidia in cattle, Eimeria bovis and Eimeria zurnii, can be differentiated on a standard fecal flotation. Oocysts of E. bovis are oval, have a micropyle, and measure 20 μm by 28 μm, whereas those of E. zurnii are spherical, lack the micropyle, and measure 15 to 22 μm by 13 to 18 μm. When oocysts are recovered on fecal flotation, the observation is usually noted as “coccidia.”
Cryptosporidium is another coccidian parasite that parasitizes the small intestine of a variety of animals, including cattle, sheep, and goats. The sporulated oocysts in the feces are colorless and transparent and are extremely tiny, only 4.5 to 5.0 μm in diameter. Diagnosis is by standard fecal flotation and stained fecal smears. Because human beings may become infected with Cryptosporidium species, feces suspected of harboring this protozoan should be handled with great care (see Fig. 6-19).
Nematodes (Roundworms): Elaeophora schneideri, the “arterial worm,” is found in the common carotid arteries of sheep in the western and southwestern United States. Microfilariae are 270 μm long and 17 μm thick, bluntly rounded cranially, and tapering caudally. They are found in the skin, usually in the capillaries of the forehead and face. Filarial dermatitis is seen on the face, poll region, and feet of sheep.
Diagnosis is by observation of characteristic lesions and identification of microfilariae in the skin. The most satisfactory means of diagnosis is to macerate a piece of skin in warm saline and examine the material for microfilariae after approximately 2 hours. In sheep, microfilariae are rare and may not be found in the skin of infected animals. Postmortem examination may be necessary to confirm the diagnosis. The prepatent period is 18 weeks or longer.
Protozoans (Unicellular Organisms): Babesia bigemina is an intracellular parasite found within the RBCs of cattle. This parasite is a large piroplasm, 4 to 5 μm long by approximately 2 μm wide. It is characteristically pear shaped and occurs in pairs, forming an acute angle within the erythrocyte. The intermediate host for this protozoan parasite is the tick Boophilus annulatus.
Nematodes (Roundworms): Dictyocaulus species are lungworms of cattle (Dictyocaulus viviparus), sheep, and goats (Dictyocaulus filaria). Adults are found in the bronchi. The prepatent period varies with the species but is approximately 28 days. Eggs usually are coughed up and swallowed and hatch in the intestine, producing larvae that may be recovered in the feces.
Larvae of D. filaria have brownish food granules in their intestinal cells, a blunt tail, and a cranial cuticular knob. They are 550 to 580 μm long. Larvae of D. viviparus also have brownish food granules in their intestinal cells but have a straight tail; they lack the cranial cuticular knob. These larvae are 300 to 360 μm in length (Fig. 6-38).

Figure 6-38 Representative eggs and larvae of Dictyocaulus species, or cattle lungworms. (From Hendrix CM, Robinson E: Diagnostic parasitology for veterinary technicians, ed 3, St Louis, 2006, Mosby.)
Muellerius capillaris often is called the “hair lungworm.” Adults are found within the bronchioles, mostly in nodules in the lung parenchyma of sheep and goats. The eggs develop in the lungs of the definitive host and the first-stage larvae are coughed up, swallowed, and passed out with the feces. They are 230 to 300 μm long. The larval tail has an undulating tip and a dorsal spine (Fig. 6-39).

Figure 6-39 First-stage larva of Muellerius capillaris, the “hair lungworm” of sheep and goats. First-stage larvae are 230 to 300 μm long. The larval tail has an undulating tip and a dorsal spine. (From Hendrix CM, Robinson E: Diagnostic parasitology for veterinary technicians, ed 3, St Louis, 2006, Mosby.)
Adult Protostrongylus species occur in the small bronchioles of sheep and goats. Again, the eggs develop in the lungs of the definitive host and the first-stage larvae are coughed up, swallowed, and passed out with the feces. These larvae are 250 to 320 μm long. This nematode’s larval tail has an undulating tip but lacks the dorsal spine. The Baermann technique is used to diagnose lungworm infection in ruminants.
Nematodes (Roundworms): Thelazia rhodesii and Thelazia gulosa are the “eyeworms” of cattle, sheep, and goats. Adult parasites may be recovered from the conjunctival sac and lachrymal duct. Examination of the lachrymal secretions may reveal eggs or first-stage larvae. Figure 6-40 shows adult Thelazia in the conjunctival sac of a cow.
Setaria cervi is the “abdominal worm” of cattle. Adults are found free within the peritoneal cavity. The sheathed microfilariae are approximately 250 μm by 7 μm. Diagnosis is by demonstration of microfilariae in blood smears. Cysticercus tenuicollis, the bladderworm (larval or metacestode stage) of Taenia hydatigena, may be found attached to the greater omentum within the abdominal cavity of many ruminants. These cysticerci are usually diagnosed on postmortem examination.
Cysticercus bovis, the bladderworm (larval or metacestode stage) of Taenia saginata, the beef tapeworm of human beings, may be found within the musculature of the bovine intermediate host. These cysticerci are colloquially referred to as “beef measles” and are usually diagnosed during postmortem meat inspection. Human beings become infected with the adult tapeworm by eating poorly cooked beef.
Parasites of the Gastrointestinal Tract
Arthropods (Larval Flies): These parasites are unusual; their adult form is an ectoparasite and their larval form is an endoparasite. Larval Gasterophilus species, or “horse bots,” parasitize the stomach of horses. Because these stages are larval or immature stages of nonparasitic adult flies, no demonstrable egg stage may be recovered from horse feces; however, adult flies do deposit eggs on the hairs of the legs of horses (Figs. 6-41 and 6-42). The third larval stage exits the gastrointestinal tract by the feces; therefore this stage may be recovered from the feces. The brown larvae are up to 20 mm in length and have dense spines on the cranial border of each segment. A pair of distinct mouth hooks is found on the cranial end of the first segment and a spiracular plate on the caudal end (Fig. 6-43). The veterinary technician should be able to identify horse bots grossly as Gasterophilus species.

Figure 6-41 Numerous eggs cemented to forelimb of a horse. (From Hendrix CM, Robinson E: Diagnostic parasitology for veterinary technicians, ed 3, St Louis, 2006, Mosby.)

Figure 6-42 Individual egg of Gasterophilus species cemented by adult female fly to hairs on a horse’s leg. Friction and moisture of horse’s licking cause the egg to hatch. Note emergence of larval bot. (From Hendrix CM, Robinson E: Diagnostic parasitology for veterinary technicians, ed 3, St Louis, 2006, Mosby.)
Nematodes (Roundworms): Habronema species and Draschia megastoma are nematodes found in the stomach of horses. Habronema microstoma and H. muscae occur on the stomach mucosa, just beneath a thick layer of mucus; D. megastoma is often associated with large, thickened fibrous nodules within the stomach mucosa. Larvae of both may parasitize skin lesions, causing a condition known as “summer sores” (see Chapter 7). The prepatent period is approximately 60 days. Larvated eggs or larvae may be recovered on a standard fecal flotation. The eggs of both genera are elongated, have thin walls, and measure 40 to 50 μm by 10 to 12 μm (Fig. 6-44).

Figure 6-44 Larvated eggs or larvae of Habronema and Draschia species may be recovered on standard fecal flotation. Eggs of both genera are elongated, have thin walls, and often contain first-stage larvae. (From Hendrix CM and Robinson E: Diagnostic parasitology for veterinary technicians, ed 3, St Louis, 2006, Mosby.)
Trichostrongylus axei is another nematode that may infect the stomach of horses. They are unusual in that they also can infect cattle and sheep. Their eggs are classified as strongyle-type eggs.
Parascaris equorum often is called the “equine ascarid” or “equine roundworm.” It is found in the small intestine of horses, particularly young foals. The prepatent period is 75 to 80 days. Eggs recovered from the feces of young horses are oval and brown. The shell is thickened, with a finely granular surface. The eggs measure 90 to 100 μm in diameter. The center of the egg contains one or two cells (Fig. 6-45). Eggs may be recovered easily on standard fecal flotation.

Figure 6-45 Characteristic ovum of Parascaris equorum, the equine ascarid or the equine roundworm. The shell is thickened, with a finely granular surface. The eggs measure 90 to 100 μm in diameter. The center of the egg contains one or two cells. (From Hendrix CM, Robinson E: Diagnostic parasitology for veterinary technicians, ed 3, St Louis, 2006, Mosby.)
Strongyles are nematodes that parasitize the large intestine of horses and are typically divided into two types: large strongyles and small strongyles. The small strongyles comprise several genera that vary in pathogenicity. The large strongyles are the most pathogenic of the strongyles. Strongylus vulgaris, Strongylus edentatus, and Strongylus equinus are the large strongyles (Fig. 6-46).

Figure 6-46 Strongyle-type ovum of horses. These eggs contain an 8- to 16-cell morula and measure approximately 70 to 90 μm by 40 to 50 μm. When these characteristic eggs are found on fecal flotation, the observation is recorded as strongyle-type ova rather than as a particular species of strongyle. (From Hendrix CM, Robinson E: Diagnostic parasitology for veterinary technicians, ed 3, St Louis, 2006, Mosby.)
Regardless of whether these endoparasites are a small strongyle or a large strongyle, their eggs are virtually identical. Identification to the species level is accomplished by fecal culture and identification of larvae. Strongyle eggs are most often observed in a standard fecal flotation. They contain an 8- to 16-cell morula and measure approximately 70 to 90 μm by 40 to 50 μm. When these characteristic eggs are found on fecal flotation, the observation is recorded as strongyle-type ova rather than as a particular species of strongyles.
Strongyloides westeri is often referred to as the “intestinal threadworm” of horses. These nematodes are unique; only a parthenogenetic female (one that can lay eggs without copulating with a male) is parasitic in the host. Parasitic males do not exist. These females produce larvated eggs measuring 40 to 52 μm by 32 to 40 μm. Eggs usually are recovered on flotation of fresh feces. The prepatent period is 5 to 7 days (see Fig. 6-7).
Oxyuris equi is the pinworm of horses. The adult worms are found in the cecum, colon, and rectum. Adult worms are often observed protruding from the horse’s anus. The adult female worms attach their eggs to the anus with a sticky, gelatinous material that produces anal pruritus in infected horses. Eggs also may be recovered from the feces. The eggs are 90 μm by 40 μm, with a smooth, thick shell. They are operculated, slightly flattened on one side, and may be larvated (Fig. 6-47). The prepatent period is approximately 4 to 5 months. Diagnosis is by finding the characteristic eggs on microscopic examination of cellophane tape impressions or by scraping the surface of the anus.

Figure 6-47 Characteristic ovum of Oxyuris equi, the pinworm of horses. The eggs are 90 by 40 μm, with a smooth, thick shell. They are operculated and slightly flattened on one side. The eggs may be larvated. (From Hendrix CM, Robinson E: Diagnostic parasitology for veterinary technicians, ed 3, St Louis, 2006, Mosby.)
Cestodes (Tapeworms): Anoplocephala perfoliata, Anoplocephala magna, and Paranoplocephala mamillana are the equine tapeworms. A. perfoliata is found in the small and large intestine and cecum. A. magna is found in the small intestine and occasionally the stomach. P. mamillana also is found in the small intestine and occasionally the stomach. The eggs of A. perfoliata have thick walls, with one or more flattened sides, and measure 65 to 80 μm in diameter. Those of A. magna are similar but slightly smaller, measuring 50 to 60 μm. The eggs of P. mamillana are oval and have thin walls, measuring 51 to 37 μm. Eggs of all three species have a three-layer egg shell, with the innermost lining called the pyriform apparatus, which is pear shaped. Eggs of all equine tapeworms can be recovered by standard fecal flotation. The prepatent period of all three species ranges from 28 to 42 days.
Protozoans (Unicellular Organisms): Eimeria leuckarti is a coccidian found in the small intestine of horses. This protozoan demonstrates unique, large oocysts (80 to 87 μm by 55 to 60 μm) with a thick wall, a distinct micropyle, and a dark brown color. These oocysts can be recovered on fecal flotation and are the largest coccidian oocysts. They are frequently observed on histopathologic examination. The prepatent period ranges from 15 to 33 days.
Protozoans (Unicellular Organisms): Babesia equi and Babesia caballi are intracellular parasites found within the RBCs of horses. They are also referred to as the equine piroplasms. Diagnosis is by observing basophilic, pear-shaped trophozoites in RBCs on stained blood smears. Trophozoites of B. equi may be round, amoeboid, or pyriform. Four organisms may be joined, giving the effect of a Maltese cross. Individual organisms are 2 to 3 μm long. Trophozoites of B. caballi are pyriform, round or oval, and 2 to 4 μm long. They occur characteristically in pairs at acute angles to each other.
Nematodes (Roundworms): Dictyocaulus arnfieldi, the equine lungworm, is found in the bronchi and bronchioles of horses, mules, and donkeys. Its eggs are ellipsoid and embryonated, measuring approximately 80 to 100 μm by 50 to 60 μm. Eggs can be recovered on fecal flotation of fresh (less than 24 hours old) feces. Larvae hatch from the eggs within a few hours after feces are passed. The prepatent period for the equine lungworm is 42 to 56 days.
Thelazia lacrymalis is the eyeworm of horses throughout the world. Adult parasites may be recovered from the conjunctival sac and lachrymal duct. Examination of the lachrymal secretions may reveal eggs or first-stage larvae.
The unsheathed microfilariae of Onchocerca cervicalis have been incriminated as causing periodic ophthalmia and blindness in horses. These may be detected by ophthalmic examination.
Parasites of the Gastrointestinal Tract
Nematodes (Roundworms): Ascarops strongylina and Physocephalus sexalatus are the “thick stomach worms” of the porcine stomach. Both of these nematodes produce thick-walled, larvated eggs that may be recovered on fecal flotation. The eggs of both species are similar. The eggs of A. strongylina are 34 to 39 μm by 20 μm and have thick shells surrounded by a thin membrane that produces an irregular outline. The eggs of P. sexalatus are 34 to 39 μm by 15 to 17 μm. The prepatent period for both species is approximately 42 days.
Hyostrongylus rubidus is referred to as the “red stomach worm” of swine. The eggs are trichostrongyle type; that is, they are oval, thin-shelled eggs. They contain four or more cells and measure 71 to 78 μm by 35 to 42 μm. These eggs may be recovered on fecal flotation. As with bovine trichostrongyles, definitive diagnosis can be made only by fecal culture and larval identification. The prepatent period is approximately 20 days.
Ascaris suum, the swine ascarid or the large intestinal roundworm, is the largest nematode found within the small intestine of pigs. The eggs may be recovered on standard fecal flotation. They are oval and golden brown, with a thick albuminous shell bearing prominent projections. These eggs measure 70 to 89 μm by 37 to 40 μm (Fig. 6-48).

Figure 6-48 Characteristic ovum of Ascaris suum, the swine ascarid or the large intestinal roundworm of pigs. The eggs are oval and golden brown, with a thick, albuminous shell bearing prominent projections. They measure 70 to 89 μm by 37 to 40 μm. (From Hendrix CM, Robinson E: Diagnostic parasitology for veterinary technicians, ed 3, St Louis, 2006, Mosby.)
Strongyloides ransomi, the intestinal threadworm of pigs, is found within the small intestine of pigs. This parasite is unique in that only a parthenogenetic female is parasitic in the host. Parasitic males do not exist. These females produce larvated eggs measuring 45 to 55 μm by 26 to 35 μm. Eggs are usually recovered in flotation of fresh feces. The prepatent period is 3 to 7 days (see Fig. 6-7).
Trichinella spiralis occurs in the small intestine of many hosts, most notably the pig. Swine become infected with T. spiralis when they ingest infective larval stages (juveniles) in undercooked meat. The larvae mature into adults in the host’s small intestine in a few weeks, and the female worms give birth to larvae. The males die after fertilizing the females, and the females die after producing larvae. The larvae enter the bloodstream of the host and, eventually, end up in the pig’s musculature.
Oesophagostomum dentatum, the “nodular worm of swine,” is found in the large intestine of swine. The prepatent period is 50 days. Their eggs are trichostrongyle type; that is, they are oval, thin-shelled eggs. They contain 4 to 16 cells and measure 40 by 70 μm. These eggs may be recovered on a standard fecal flotation. As with bovine trichostrongyles, definitive diagnosis is made only by fecal culture and larval identification.
Trichuris suis is commonly called the whipworm, infecting the cecum and colon of swine. See the section on nematode parasites of the gastrointestinal tract of dogs and cats for details on gross morphology of adult worms. The egg of the whipworm is described as trichinelloid or trichuroid. It has a thick, brown, barrel-shaped shell with plugs at both ends. The eggs are unembryonated (not larvated) when laid. Eggs of porcine whipworms measure 50 to 60 μm by 21 to 25 μm. The prepatent period is 42 to 49 days.
Acanthocephalans (Thorny-Head Worms): Macracanthorhynchus hirudinaceus is the “thorny-head worm” of the small intestine of swine. “Thorny head” describes the spiny proboscis, which it embeds as an anchor into the small intestinal mucosa of the host. The eggs have a triple-layer shell, are oval, and measure 67 to 100 μm by 40 to 65 μm (Fig. 6-49). The eggs may be recovered on a standard fecal flotation. The prepatent period is 60 to 90 days.

Figure 6-49 Ova of Macracanthorhynchus hirudinaceus, the “thorny-head worm” of the small intestine of swine. The eggs have a triple-layered shell, are oval, and measure 67 to 100 μm by 40 to 65 μm. (From Hendrix CM and Robinson E: Diagnostic Parasitology for Veterinary Technicians, ed 3, St Louis, 2006, Mosby.)
Protozoans (Unicellular Organisms): Balantidium coli is the ciliated protozoan found in the large intestine of swine. Although commonly observed during microscopic examination of fresh diarrheic feces, it is generally considered nonpathogenic. Two morphologic stages may be found in feces: the cyst stage and the motile trophozoite stage. Both stages may vary in size. This is a large protozoan parasite. The trophozoites may be 150 μm by 120 μm, with a sausage- to kidney-shaped macronucleus. It is covered with numerous rows of cilia and moves about the microscopic field with lively motility. The cyst is spherical to ovoid and 40 to 60 μm in diameter, with a slight greenish-yellow color. Both of these stages may be easily recognized by microscopic examination of the intestinal contents or fresh, diarrheic feces. Figure 6-50 shows the trophozoite stage of B. coli recovered on fecal flotation. Figure 6-51 shows B. coli in histopathologic section.

Figure 6-50 Trophozoite stage of Balantidium coli, the “ciliated protozoan” found in the large intestine of swine. The trophozoites may be 150 by 120 μm, with a sausage- to kidney-shaped macronucleus. They are covered with numerous rows of cilia and move about the microscopic field with lively motility. The cyst is spherical to ovoid and 40 to 60 μm in diameter, with a slight greenish-yellow color. (From Hendrix CM, Robinson E: Diagnostic parasitology for veterinary technicians, ed 3, St Louis, 2006, Mosby.)

Figure 6-51 A, Balantidium coli of swine in histopathologic section. This photomicrograph was taken at low magnification. Note that B. coli is quite large and easily visible (arrows). B, B. coli of swine in histopathologic section. This photomicrograph was taken at higher magnification than A. (From Hendrix CM, Robinson E: Diagnostic parasitology for veterinary technicians, ed 3, St Louis, 2006, Mosby.)
Cryptosporidium is a coccidian that parasitizes the small intestine of a wide variety of animals, including swine. The sporulated oocysts in the feces are colorless and transparent and measure only 4.5 to 5.0 μm. Diagnosis is by standard fecal flotation and stained fecal smears. Because people may become infected with Cryptosporidium species, feces suspected of harboring this protozoan should be handled with great care (see Fig. 6-19).
Isospora suis is the coccidian that parasitizes the small intestine of swine, especially young piglets. Oocysts are usually found on flotation of fresh feces. They are subspherical, lack a micropyle, and measure 18 to 21 μm (Fig. 6-52). Postmortem diagnosis in piglets exhibiting clinical signs, but not shedding oocysts, can be achieved by direct smear of the jejunum stained with Diff-Quik. Diagnosis is by observation of the banana-shaped merozoites. The prepatent period is 4 to 8 days.
Nematodes (Roundworms): Metastrongylus apri, the swine lungworm, is found within the bronchi and bronchioles of pigs. The oval, thick-walled eggs measure 60 μm by 40 μm and contain larvae. Eggs can be recovered on fecal flotation using a flotation medium with a specific gravity greater than 1.25 or by the fecal sedimentation technique. The prepatent period is approximately 24 days.
Nematodes (Roundworms): Stephanurus dentatus, the swine kidney worm, is found in the kidney, ureters, and perirenal tissues of pigs (Fig. 6-53). Their eggs are strongyle type; that is, they are oval, thin-shelled eggs containing 4 to 16 cells and measuring 90 to 120 μm by 43 to 70 μm. Eggs may be recovered from the urine by urine sedimentation. The prepatent period is extremely long, approximately 9 to 24 months.

Figure 6-53 Egg of Stephanurus dentatus, the swine kidney worm. These eggs are strongyle type; that is, they are oval, thin-shelled eggs containing 4 to 16 cells and measuring 90 to 120 μm by 43 to 70 μm. Eggs can be recovered Reprinted from the urine by urine sedimentation. (From Hendrix CM, Robinson E: Diagnostic parasitology for veterinary technicians, ed 3, St Louis, 2006, Mosby.)
Cysticercus cellulosae, the bladderworm (larval or metacestode stage) of Taenia solium, the pork tapeworm of human beings, may be found within the musculature of the porcine intermediate host. These cysticerci are colloquially referred to as “pork measles” and are usually diagnosed during postmortem meat inspection. Human beings become infected with the adult tapeworm Taenia solium by eating poorly cooked pork containing cysticerci. Human beings may become infected with Cysticercus cellulosae in the muscles or within nervous tissue such as the brain or the eye by ingesting the eggs of T. solium.
Trichinella spiralis is found in many species of carnivores and omnivores but is often associated with raw or undercooked pork. Animals (including human beings) become infected with T. spiralis when they ingest infective larval stages (juveniles) in meat. The larvae mature into adults in the host’s small intestine in a few weeks, and the female worms give birth to larvae. The males die after fertilizing the females, and the females die after producing larvae. The larvae enter the bloodstream of the host and, eventually, end up in the pig’s musculature. Within the muscles, the larvae mature into infective encysted larvae. The next host becomes infected when it eats these larvae. Trichinosis is probably best known as a parasite that human beings contract from eating raw or undercooked pork. It is usually detected by proper meat inspection. Most recent outbreaks of trichinosis in the United States have been traced to pork products from pigs that have not been inspected and that have been privately slaughtered.
Parasites can infect the oral cavity, esophagus, stomach, small and large intestines, and other internal organs of animals. Detection of these parasites involves collection and microscopic examination of feces. Diagnosis is usually by finding life cycle stages of the parasite within the feces. These stages include eggs, oocysts, larvae, segments (tapeworms), and adult organisms. Veterinary technicians may perform the following procedures to detect parasitic infections.
Fecal samples collected for routine examination should be as fresh as possible. Specimens that cannot be examined within a few hours of excretion should be refrigerated or mixed with an equal part of 10% formalin. The need for fresh feces stems from the fact that eggs, oocysts, and other life cycle stages may be altered by development, making diagnosis extremely difficult.
Several methods are used for collecting feces from companion animals. An owner may collect a fecal sample immediately after the animal has defecated. The feces can be stored in any type of container, such as a zippered plastic bag or a clean, small jar. Veterinary hospitals may dispense containers to their clients for this purpose. In either case, only a small amount of feces (1 teaspoon) is required for proper examination. All specimens should be properly identified with the owner’s name, animal’s name, and species of animal.
Fecal samples also may be collected directly from the animal at the veterinary hospital by using a gloved finger or fecal loop. If a glove is used, the feces may remain in the glove, with the glove turned inside out, tied, and labeled. Samples collected with a fecal loop should be used for direct examination only because the amount collected is relatively small.
Fecal specimens collected from livestock may be obtained either directly from an individual animal’s rectum or from a number of animals to make up a pooled sample. Samples collected directly from an individual animal with a gloved hand can remain in the glove, with the glove turned inside out, tied, and labeled.
Pooled samples are collected from a number of animals housed together and then commingled in a single container. These samples are used to get an idea of the degree of infection within the group. Pooled samples can be collected in any type of container as long as it is clean and can be tightly sealed. These samples should be labeled with the species, pen or group number, owner, and time of collection.
The following precautions should be taken during fecal examination:
• Fecal samples are handled with care. The feces may contain parasites, bacteria, or viruses that are zoonotic (i.e., animal diseases that can be transmitted to people). Appropriate clothing, such as a clean laboratory coat or jacket and latex gloves, should be worn. If gloves are not worn, hands should be frequently washed with soap and water. No food or drink should be allowed in the examination area. Likewise, workers should refrain from applying makeup or adjusting contact lenses. Laboratory coats should never be worn outside the veterinary clinic to reduce the chances of spreading any infections.
• The laboratory area is cleaned thoroughly after the fecal examinations are completed. Spilled materials create a hazardous area in which to work and could pose a serious threat to staff members’ health.
• Accurate and thorough records are maintained. Records should contain the date, owner’s name, and any parasites found in the sample. If the sample is negative, it should be recorded as such.
The following characteristics of the feces should also be recorded and reported to the veterinarian:
• Consistency: Fresh feces should be somewhat formed depending on the species of animal. Diarrhea or constipation could be the result of a parasitic infection.
• Color: Fecal color may be affected by the food an animal eats. Malabsorption or a parasitic infection also may alter the color of feces.
• Blood: Blood may impart a dark reddish-brown color to feces or it may appear as bright red streaks in the feces. In either case, blood may indicate a severe parasitic infection or other serious intestinal disease. Blood in the feces is an important clinical finding and should be brought to the attention of the veterinarian. Digested blood has a dark, tarry appearance.
• Mucus: Mucus in the feces can be a result of digestive disorders or a parasitic infection. In either case, its presence should be reported to the veterinarian.
• Parasites: Adult parasites or tapeworm segments can be found in the feces. Adult roundworms resemble strings of spaghetti, and tapeworm segments look more like pieces of cooked rice. Tapeworm segments may be identified by microscopic examination (Procedure 6-1). The segments of two common tapeworms infecting dogs and cats are shown in Figure 6-54. Figure 6-55 shows common tapeworm segments, Moniezia species, found in cattle feces, and Anoplocephala species, found in horse feces.
Occasionally, a client may submit a dried tapeworm segment. To identify the tapeworm species, the dried segments must be soaked in saline for 1 to 4 hours. Once the segments are rehydrated, they may be identified by size, shape, and the eggs contained within.
Segments of some tapeworm species do not contain eggs, and some segments may have expelled their eggs before the examination was conducted. In either case, a tapeworm segment may be identified as such by finding small mineral deposits (calcareous bodies) within the segment (Fig. 6-56). This is done by crushing the tapewormlike segment between two glass slides and examining the material with a microscope.
Microscopic examination of feces is the most reliable method to detect parasitic infections. A microscope with 4×, 10×, and 40× objectives are required for proper examination of a fecal specimen (see Chapter 1). A mechanical stage is helpful. A micrometer is also recommended but is not required.
Fecal specimens should be examined routinely with the 10× objective. The examination should begin at one corner of the slide and end at the opposite corner, moving over the slide in a systematic pattern (Fig. 6-57). The microscope should be continually focused with the fine-tuning knob during the examination. The initial plane of focus should be that of air bubbles because most eggs are found in this plane. Any material found during the initial scan, including parasite eggs, may be more closely examined using the more powerful objectives.

Figure 6-57 A scheme of movement of the microscopic field to examine the area under the cover slip thoroughly. (From Hendrix CM, Robinson E: Diagnostic parasitology for veterinary technicians, ed 3, St Louis, 2006, Mosby.)
Calibration of the Microscope: The size of the various stages of many parasites is often important for correct identification. Some examples are Trichuris versus Capillaria eggs and Dipetalonema versus Dirofilaria microfilariae. Accurate measurements are easily obtained with the use of a calibrated eyepiece on the microscope. Calibration must be performed on every microscope to be used. Each objective (lens) of the microscope must be individually calibrated. Calibration of the microscope is described in Chapter 1. Once the calibration procedure has been completed for all magnifications, the information is recorded on a label and attached to the calibrated microscope, such as in the following example:

To measure an object such as a parasite egg, one end of the egg is placed on the zero mark and the number of divisions to the other end of the egg is counted. The number of divisions counted is multiplied by the calibration factor for the objective being used. For example, a trichostrongyle egg is 24 divisions long and 13.5 divisions wide when measured with the 40× objective. The calibration factor for the 40× objective is 2.5. Therefore the egg is:
To measure a microfilaria, the head (the anterior end) is aligned with the zero mark and the number of divisions to the end of the tail (the posterior end) is counted. To measure round parasite eggs, the technician should measure through the middle of the egg. For more accurate measurements, the higher objective is used (40× instead of 10×).
Examination of Direct Smears: A direct smear of feces is used to estimate an animal’s parasite burden rapidly. This procedure also is used to detect some of the motile protozoa found in feces.
Advantages of direct smears include short preparation time and minimal equipment required to run the procedure. Disadvantages include the small amount of feces examined, which may not be sufficient enough to detect a low parasite burden, and the amount of extraneous fecal debris on the slide, which could be confused with parasitic material.
A fecal sample for a direct smear preparation may be obtained from an animal using a fecal loop or a rectal thermometer (after measuring the animal’s temperature). Either way, only a very small amount of feces is needed (Procedure 6-2).
The following methods are used to concentrate parasitic material in feces. A concentration technique makes examination of a large amount of feces possible in a relatively short time. Also, a low parasite burden can easily be identified. Two types of procedures are most often used in veterinary hospitals: flotation and sedimentation.
Flotation Solutions: Fecal flotation methods are based on the specific gravity of parasitic material and fecal debris. Specific gravity refers to the weight of an object compared with the weight of an equal volume of water. The specific gravity of most parasite eggs is between 1.100 and 1.200 g/mL, whereas the specific gravity of water is 1.000.
To allow for flotation of parasite eggs, oocysts, and other life cycle stages, the flotation solution must have a higher specific gravity than that of the parasitic material (Fig. 6-58). Several salt and sugar solutions work well for flotation (Procedure 6-3). Most have a specific gravity of 1.200 to 1.250. In this range, heavy fecal debris sinks to the bottom of the container, whereas parasitic material rises to the top of the solution.

Figure 6-58 Measuring the specific gravity of a flotation solution with a hydrometer. (From Hendrix CM, Robinson E: Diagnostic parasitology for veterinary technicians, ed 3, St Louis, 2006, Mosby.)
Sodium nitrate solution is the most common fecal flotation solution used in veterinary hospitals today. This solution is efficient for floating parasite eggs, oocysts, and larvae. It may be purchased with commercial diagnostic test kits or in individual aliquots. The major disadvantage of using sodium nitrate is the expense. Sodium nitrate also forms crystals and distorts eggs if allowed to sit longer than 20 minutes.
Another solution commonly used for flotation is sugar solution. Sugar solution is inexpensive and does not crystallize or distort eggs. Sugar solution may be made anywhere and has a long shelf life. Although sticky to work with, spilled sugar solution may be removed with warm, soapy water.
Zinc sulfate solution is more commonly used in diagnostic laboratories. Zinc sulfate floats protozoal organisms with the least amount of distortion. It generally is used in combination with one of the previously mentioned solutions.
The least desirable solution used is saturated sodium chloride solution. This solution corrodes laboratory equipment, forms crystals, and severely distorts parasite eggs. Saturated sodium chloride solution is also a poor flotation medium because the maximum specific gravity obtainable is 1.200, allowing heavier eggs to remain submerged.
Standard Fecal Flotation: The standard or simple fecal flotation is one of the most common flotation techniques used in veterinary hospitals (Procedure 6-4). This technique uses a test tube or vial in which feces and flotation solution are mixed (Fig. 6-59). A cover slip or microscope slide is placed on top of the test tube and the unit is allowed to sit undisturbed. Any parasite eggs in the feces float to the top and adhere to the underside of the cover slip or microscope slide. The cover slip or slide is then removed and microscopically examined for parasitic material. Although the standard flotation technique is easy to perform, it is less efficient at floating parasitic material than the centrifugal technique, described later.

Figure 6-59 Vial filled with flotation solution, showing appearance of the meniscus. (From Hendrix CM, Robinson E: Diagnostic parasitology for veterinary technicians, ed 3, St Louis, 2006, Mosby.)
Commercial flotation kits use the same principle as the standard flotation technique. These kits contain a vial with a filter; some also include prepared flotation solution. Examples of commercial flotation kits include Fecalyzer (EVSCO Pharmaceuticals, Buena, NJ), Ovassay Plus (Synbiotics, San Diego, CA), and Ovatector (BGS Medical Products, Venice, FL) (Fig. 6-60). These kits are simple to use but expensive when compared with the simple flotation technique. Some practices reduce the expense by washing and reusing the vials and filters; this practice should be discouraged.
Centrifugal Flotation: Centrifugal flotation for parasite eggs, oocysts, and other parasitic material is the most efficient method available. It requires less time to perform than the standard flotation method. The only drawback to this procedure is that it requires a centrifuge with a rotor that can hold 15-ml centrifuge tubes (see Chapter 1). If such a centrifuge is available, centrifugal flotation is preferred because it is easy to perform and samples can be run individually or in batches.
If testing multiple samples, the veterinary technician may want to use a numbering system to keep the samples in order. A number is assigned to the patient and that number is written on the corresponding centrifuge tube with a marking pen. This minimizes the chances of error (Procedure 6-5).
Fecal Sedimentation: Fecal sedimentation concentrates parasite eggs, oocysts, and other parasitic material by allowing them to settle to the bottom of a tube of liquid, usually water. A disadvantage of this technique is the amount of fecal debris that mixes with the parasitic material, which makes microscopic examination somewhat difficult.
This procedure is used to detect heavy eggs that would not float in flotation solution or eggs that would become distorted by the flotation solution. Trematode (fluke) eggs are often considered too heavy for flotation and are often found with fecal sedimentation. Although some flotation solutions can be adjusted to a specific gravity of 1.300 to float these eggs, such solutions are not routinely used because some distortion may occur (Procedure 6-6).
Quantitative procedures are used to determine the number of eggs or oocysts present in each gram of feces. These procedures are used as a rough indication of the number of parasites present within a host. Their usefulness is limited, however, by the fact that the various parasite species produce different numbers of eggs. Also, egg production by the parasites may be sporadic, and the number of eggs may not correlate with the number of parasites present. The last item is the most significant disadvantage because, in some cases, clinical signs of disease are caused by immature parasites that have not yet begun producing eggs or larvae.
Several quantitative procedures can be performed in veterinary hospitals. These include the Stoll egg count technique, the modified Wisconsin double centrifugation technique, and the McMaster technique. These procedures are fairly easy to perform; each requires its own specialized equipment. Two quantitative techniques are described in Procedures 6-7 and 6-8. Other quantitative procedures may be found in the references listed at the end of this chapter.
Protozoal Trophozoites: All the previously described procedures can be used to detect protozoal cysts. However, some protozoans do not form cysts and pass out of the host in the trophozoite form. Trophozoites are one-cell, motile organisms that lack the rigid wall of a cyst, making flotation without distortion or death of the trophozoite impossible. Therefore the direct smear technique, with saline and a stain, is the preferred procedure for examination of a fecal sample for protozoal organisms.
In a direct smear, trophozoites may be recognized by their movement. Balantidium coli is bean shaped and covered with tiny hairs, or cilia. It moves in a slow, tumbling fashion. Giardia species are tear shaped and have five to eight flagella. They move with a jerky motion. Trichomonads are long, slender organisms with a single flagellum attached to the dorsal surface, forming a sail-like structure that ripples as the organism glides through debris. Amoebas move with a flowing motion, extending a part of the body (pseudopod) and moving the rest of the body after it.
Stains also may be used to recognize certain structural characteristics of trophozoites and cysts. Lugol’s iodine and new methylene blue are common stains used with the direct smear procedure. These stains do not preserve the slide but do facilitate examination of the specimen, making identification easier.
If a protozoal parasite cannot be identified on direct smears, fecal smears containing protozoal trophozoites can be dried, stained with Diff-Quik, Wright’s, or Giemsa stain, and sent to a diagnostic laboratory. Many other procedures are used for staining and preserving protozoal trophozoites. Most of these procedures are used in diagnostic laboratories and are not explained in this text.
Coccidia: Several coccidian parasites require special staining techniques for identification. Two procedures are discussed.
The acid-fast staining technique is used to identify Cryptosporidium species in feces. Cryptosporidium is a parasite of the gastrointestinal tract of many animals, including human beings. The oocysts are 2 to 8 μm in diameter and are almost undetectable in flotation solution to the inexperienced eye. Acid-fast staining can help detect the oocysts in a fecal smear.
The second procedure uses Diff-Quik stain for identification of Isospora species. Isospora species are coccidia found in the gastrointestinal tract (especially the jejunum) of many animals, but they are of most concern in pigs. This parasite can cause the death of many piglets before any oocysts are found in the feces by conventional flotation methods. Therefore an intestinal mucosal scraping must be stained and examined for other diagnostic stages (schizonts, merozoites) of this parasite. This procedure involves scraping the mucosa of the jejunum and smearing the scrapings onto microscope slides. After the slides are air dried, they are stained with Diff-Quik and examined with the oil-immersion objective.
For accurate results with either of these procedures, several samples should be examined. If such examination is not possible, feces or intestines may be sent to a diagnostic laboratory. Collection and shipping of parasitic specimens are described subsequently.
Antigen tests for Giardia and Cryptosporidium are available and may be used for their detection. See Chapter 8 for more details on antigen testing.
Fecal cultures involve rearing infective larvae of strongyles, trichostrongyles, or hookworms for identification. Several techniques are available for this purpose.
The first procedure uses a covered glass jar rinsed with 0.1% sodium carbonate solution. Sodium carbonate solution is used to inhibit mold growth while allowing the parasite eggs to develop. Formed feces are placed in the jar, which is then stored at room temperature in a dark area for 7 to 10 days. The contents of the jar should be kept moist but not soggy. If no water droplets are seen condensing on the inside of the jar, a few drops of water or sodium carbonate are added. Vermiculite or sand should be added to bovine feces or feces that contain a lot of water.
Larvae may be found in the condensation droplets in the culture jar. The veterinary technician may collect the larvae by rinsing the jar with a small amount of water, collecting the rinse, and concentrating the larvae by centrifugation. The larvae found in the sediment after centrifugation are placed on a microscope slide and examined after cover slip application. The slide is then briefly heated with a match to “relax,” or straighten, the larvae and curtail their movement.
During examination for larvae, the numbers of larvae do not necessarily correlate with numbers of eggs present in the feces. Development from egg to larva may take longer with some species than with others, and some parasite species may produce more eggs than others. For example, Haemonchus contortus and Strongyloides papillosus are found in greater numbers and their eggs develop faster than those of Trichostrongylus and Cooperia species.
Culture of canine feces for Strongyloides stercoralis filariform larvae uses the same technique previously described. Most filariform larvae appear within 24 to 48 hours. Rhabditiform larvae may be evident first. If this occurs, the sample should be allowed to stand for no less than 96 hours so that the larvae can mate and produce filariform larvae.
Another method uses a covered Petri dish and filter paper. Feces are placed in the middle of a piece of moistened filter paper, which is then placed in the Petri dish. The Petri dish is covered and placed in a dark area at room temperature for 7 to 10 days. The dish is rinsed and the rinse is collected as previously described. Technicians who want to perform a fecal culture and identify larvae should refer to the chapters on larval identification in the reference by Bowman listed at the end of this chapter.
Necropsy (postmortem examination) is an important method of diagnosing many diseases, including parasitism. The types of lesions produced by immature parasites, any adult parasites found in the body cavity and tissues, and histopathologic examination of infected tissues are used in diagnosis. Veterinary technicians are responsible for the samples collected, making sure they are properly contained, preserved, labeled, and shipped.
Two methods are used to recover parasites from the digestive tract at necropsy: the decanting method and the sieving method (Boxes 6-1 and 6-2). With either method, the veterinary technician must separate the different parts of the digestive tract and work with the contents of each individually.
Parasites recovered from the digestive tract may be preserved in 70% alcohol or 10% neutral buffered formalin for later identification. Occasionally bladderworms or cysticerci may be found attached to the viscera of domestic animals. These should be handled with care because the fluid within the bladder can be allergenic and may also be zoonotic. To identify the parasites recovered, the veterinary technician should consult the references listed at the end of this chapter. If in-hospital diagnosis is not possible, the samples may be preserved as previously described and sent to a diagnostic laboratory for identification.
Any parasitologic specimen shipped to a diagnostic laboratory should be preserved with alcohol or formalin unless otherwise directed by laboratory personnel. Specimens should be packaged in a leak-proof container and sealed with Parafilm (American National Can, Greenwich, CT.) or tape. If specimen containers are found leaking, the shipment will not be delivered. Feces can be sent fresh or mixed at a ratio of 1:3 with 10% formalin. Whole parasites or segments can be preserved in alcohol or formalin and placed in a leak-proof container.
All specimen containers should be labeled with the site from which the specimen was obtained; the owner’s name; the animal’s species, name, or identification number; and the referring veterinarian (including telephone number and address). The labeled specimen container should be placed in a shock-proof shipping container to prevent breakage during shipping. Styrofoam containers filled with shredded newspaper work well for shipping parasitologic specimens.
A cover letter should be included with the specimen and should contain a brief history of the animal, findings at necropsy, and the reason for submitting the samples to the laboratory (e.g., fecal examination, special staining, species identification). Without this background information, the diagnostic laboratory is unlikely to provide accurate results.
Cellophane Tape Technique: The cellophane tape technique is used to detect the equine pinworm Oxyuris equi (Procedure 6-9). Pinworms are nematodes found in horses; rodents; rabbits; and primates; including human beings. They live in the colon and, as adults, migrate out the rectum to lay eggs on the skin around the anus. The eggs are contained within a sticky substance and fall off as the substance hardens or as the animal scratches. For this reason, pinworm eggs usually are not seen in a routine fecal examination (see Fig. 6-47).
Baermann Technique: The Baermann technique is used to recover nematode larvae from feces, tissues, or soil. This technique uses warm water to stimulate larvae to move about. As the larvae do so, they sink to the bottom of the funnel for collection and identification (Procedure 6-10). This technique is performed with a Baermann apparatus. The apparatus consists of a ring stand and ring holder, a glass funnel with a piece of rubber tubing on the end, a clamp, and a wire net or cheesecloth. With the apparatus set up as shown in Figure 6-61, the sample is placed on the wire screen or cheesecloth and warm water is added to barely cover the sample. All air bubbles are allowed to flow from the tube of the funnel by releasing the clamp. The apparatus is allowed to sit undisturbed for 12 to 24 hours.

Figure 6-61 Baermann apparatus is used to recover larvae of roundworms from feces, soil, or animal tissues. This apparatus is most useful in recovering larvae of lungworms. (Reprinted from Hendrix CM, Robinson E: Diagnostic parasitology for veterinary technicians, ed 3, St Louis, 2006, Mosby.)
A drop of fluid from the bottom of the funnel is removed (usually the first drop) and placed on a microscope slide. If any larvae are found swimming on the slide, the slide is heated with a match to render them immobile.
Larvae recovered from fresh large animal feces are almost always those of lungworms. Larvae from Strongyloides stercoralis can be found in fresh canine feces. If the feces are not fresh, many types of parasitic and nonparasitic larvae and adults may be seen.
Dirofilaria immitis, the canine heartworm, is the most important parasite of the vascular system in domestic animals in the United States. For this reason, in-hospital blood examinations are commonly performed to detect heartworms.
The following procedures can be performed by veterinary technicians to identify D. immitis. As previously mentioned, a clean environment and proper handling of samples are vital for quality control in any laboratory. Any sample handled improperly may result in inaccurate results.
Sterile equipment and alcohol are required for collecting a blood sample from an animal. Blood may be collected using by a syringe and needle or a Vacutainer (Becton Dickinson, Rutherford, NJ). All samples should be labeled with the owner’s name, animal’s name, and date of collection. (See Chapter 2 for more details on blood collection.)
Microfilariae are more numerous in the bloodstream at certain times of the day. To increase the probability of collecting microfilariae, blood should be collected in the afternoon because the microfilariae of D. immitis are most numerous in the circulating blood at this time.
General observations of the blood should be noted. For example, a blood sample that appears watery may reflect anemia. Clinical pathology tests on the blood also may aid in diagnosis of parasitism. Heartworm microfilariae may be seen during the differential white blood cell (WBC) count. A high eosinophil count may also indicate parasitism (Procedure 6-11).
Direct examination of the blood for microfilariae is the simplest procedure to perform (Procedure 6-11). This procedure detects movement of microfilariae and other parasites among the RBCs. As with direct examination of feces, direct examination of blood requires only a small sample. However, unless parasites are present in large numbers, they may be missed. For this reason, the direct smear is not a good technique for detecting microfilariae.
Microfilariae of primary interest are those of D. immitis, the canine heartworm, and Dipetalonema (Acanthocheilonema) reconditum, a subcutaneous parasite of dogs. Differentiation between the two is extremely important because treatment for heartworms is expensive, somewhat stressful, and often involves use of extremely toxic compounds.
In a direct blood smear, microfilariae of Dirofilaria species coil and uncoil, whereas those of Dipetalonema species may glide smoothly across the slide. However, this is not always the case. Also, the number of Dirofilaria species microfilariae in a sample is greater than that of Dipetalonema species. Again, however, this is not always the case. Direct examination of the blood is used to determine only the presence of microfilariae, not the type. For this, a concentration technique that “relaxes” and stains microfilariae is used. These procedures are discussed later.
Trypanosomes are another type of parasite found in the blood. These protozoa occur in tropical areas and occasionally in the United States. Trypanosomes can be seen swimming among the cells of a diluted blood smear (single-cell thickness) but are more easily identified in stained smears.
Microfilariae can also be found in large animals. Setaria is a long white nematode found in the serous membranes of cattle and horses. Adults are most often seen during abdominal surgery, and microfilariae are found during differential WBC count.
The thin blood smear is prepared and stained in exactly the same way as a blood smear for a differential WBC count. The procedure is described in Chapter 2. When doing a differential WBC count on an animal, the veterinary technician should note any parasitic organisms seen. Microfilariae occasionally may be found. Because of their size, microfilariae usually are found along the feathered edge of the blood film. Because differentiation of the microfilariae is not possible in a thin blood smear, other procedures must be performed for identification. Trypanosomes, protozoans, and rickettsiae also may be found among or within cells. As with the direct smear procedure, a small blood sample is used and mild parasitic infections may be missed.
A thick blood smear examines a slightly greater volume of blood than does a thin blood smear. Again, microfilariae may be seen, but they cannot be easily differentiated by this method (Procedure 6-12).
The buffy coat method is a concentration technique used on a small volume of blood. When blood is placed in a microhematocrit tube and centrifuged for determining the packed cell volume (PCV), it separates into three layers: plasma, WBC layer (buffy coat), and RBC layer (Fig. 6-62). Microfilariae can be found on the surface of the buffy coat layer (Fig. 6-63). This technique is quick and may be performed in conjunction with a PCV and total protein evaluation. However, differentiation of microfilariae is not possible (Procedure 6-13).

Figure 6-62 Buffy coat in a hematocrit tube. (From Hendrix CM, Robinson E: Diagnostic parasitology for veterinary technicians, ed 3, St Louis, 2006, Mosby.)

Figure 6-63 Microfilaria in a buffy coat smear from canine blood. (From Hendrix CM, Robinson E: Diagnostic parasitology for veterinary technicians, ed 3, St Louis, 2006, Mosby.)
The following concentration techniques may be used for differentiating D. immitis from D. reconditum.
Modified Knott’s Technique: The modified Knott’s technique is a simple procedure that allows differentiation of microfilariae (Procedure 6-14). This technique concentrates, relaxes, and stains microfilariae while lysing RBCs to make the microfilariae more visible.
Figures 6-64 and 6-65 and Table 6-1 show the characteristics that may be used when identifying microfilariae. The veterinary technician should always examine as many microfilariae as possible because mixed infections can occur. The most accurate method for differentiation is measuring the length and width of the body. However, with some practice, general characteristics of the microfilariae may be used for identification if a means of measuring microfilariae is not available.
TABLE 6-1
Differentiation of Microfilariae Using the Modified Knott’s Technique
| Dirofilaria Immitis | Dipetalonema Reconditum | |
| Body length | 310 μm | 290 μm |
| Mid-body width | 6 μm | 6 μm |
| Head | Tapered | Blunt |
| Tail | Straight | Hooked* |
Filter Technique: Filter techniques are a common method used in veterinary practices for detection of microfilariae in the blood. An excellent diagnostic kit, the Di-Fil Test Kit (EVSCO Pharmaceuticals, Buena, NJ), is available for this procedure. This kit comes complete with filters, lysing solution, stain, and directions for use.
Most kits require 1 ml of whole blood to test for heartworms. The blood is mixed with nine parts of lysing solution and passed through a filter. The filter is rinsed, removed, and placed on a slide. A drop of stain is added, a cover slip is applied, and the filter is microscopically examined for microfilariae (Fig. 6-66). Differentiation of microfilariae is possible but difficult with the filter technique. If microfilariae are present, other diagnostic procedures are recommended for identification purposes.
Enzyme-Linked Immunosorbent Assay: Enzyme-linked immunosorbent assay (ELISA) kits do not directly detect microfilariae but instead test the host’s response to the parasites. These types of tests can be used for differentiating D. immitis from D. reconditum. They can be used to identify an occult heartworm infection, that is, when microfilariae are not found to be circulating in the peripheral blood. An occult infection can occur in one of several scenarios: when only one adult is present, when only one sex of adult worms is present (all male worms or all female worms), when the adults are unable to reproduce, when the animal’s immune system removes microfilariae as they are produced, or when an animal has been treated with drugs that kill circulating microfilariae or render the adults sterile. In all these scenarios, circulating microfilariae would not be found in the peripheral blood.
Some ELISA kits detect the host’s antibody response to the adult heartworms, whereas others detect the host’s antibody response to the microfilariae (see Chapter 8). A variety of commercially available ELISA tests for the detection of antigens of adult D. immitis in both dogs and cats are routinely used in veterinary clinical practice. Test kits that detect circulating antibody are also available although not widely used. The following examples are just a few of the many commercially available heartworm antigen test kits available on the market today: SNAP Heartworm Antigen Test Kit (IDEXX Laboratories, Westbrook, ME), SNAP Feline Heartworm Antigen Test Kit (IDEXX Laboratories), DiroCHEK Canine Heartworm Antigen Test Kit (Synbiotics Corporation, San Diego, CA), and Reference Laboratory Heartworm Test (antigen) (HESKA Veterinary Diagnostic Laboratories, Fort Collins, CO). One of the first actions that the veterinary technician should take is to read the manufacturer’s instructions carefully. As with any procedure, ELISA immunodiagnostic tests should be performed exactly according to the manufacturer’s directions and in a clean environment to avoid contamination. These ELISA tests are economical and expeditious. Most of the tests rely on a color change in the test kit to determine whether an animal is infected with adults of D. immitis. The veterinary technician should rely on caution when using these diagnostic tests because a chance exists for the occurrence of both false-negative and false-positive results in infected and uninfected dogs and cats. In addition, these tests should not be used as a sole means of diagnosis; occasionally a negative result coincides with the finding of microfilariae in the blood, and sometimes such results throw doubt regarding the credibility of these tests. Antigen tests are useful in heartworm diagnosis; however, the veterinary technician should be aware of their limitations as a sole screening test.
Miscellaneous Tests: Another type of heartworm diagnostic test kit (Heartworm Identification Test, ImmunoVet, Tampa, FL) works on the same principle as the Knott’s and filter techniques, except the microfilariae remain alive. This test relies on the movement of the microfilariae, which can be unreliable at times.
Other tests use special stains to bring out certain characteristics of the microfilariae. These procedures are too cumbersome to be useful in private practice and usually are performed in diagnostic laboratories.
Bowman, DD, Lynn, RC, Eberhard, ML. Georgi’s parasitology for veterinarians, ed 8. Philadelphia: WB Saunders, 2003.
Hendrix, CM, Robinson, E. Diagnostic parasitology for veterinary technicians, ed 3. St Louis: Mosby, 2006.
Sloss, MW, et al. Veterinary clinical parasitology, ed 6. Ames, IA: Iowa State University, 1994.